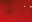

JA JAN N 20 20223 3 萬人見證 從「癲賭」人生到靠主得勝重生 張文強 特稿 「兔」氣揚眉 吳宗文牧師 封面故事 由苦瓜乾到喜樂婆婆 小金子九十載屬天路 小金子

VOL.
magazine@media.org.hk
顧問團:(排名不分先後) 李炳光牧師 司徒永富博士 吳宗文牧師 梁廷益牧師 陳耀南教授 吳宣倫博士 梁燕城博士 陳歐陽桂芬女士 區應毓牧師 許朝英先生 楊永祥先生 小金子女士 林慶儀小姐 呂宇俊博士 林旭輝先生 杜惠卿女士 編輯顧問:吳思源先生 攝影顧問:謝明莊先生 法律顧問:鄭嘉駿律師 督印:袁文輝
執行總編輯:黃耀榮 編輯部:胡皓恩 陳靜怡 美術設計及製作部:李曉超 伍君慧 攝影部:劉青麟 車耀開 出版:影音使團有限公司
地址:香港九龍觀塘鴻圖道一號2樓2-3室 電話:(852)2209 6280 傳真:(852)2309 2739 電郵:magazine@media.org.hk 網址:www.media.org.hk / www.creation-tv.com 廣告部:郭佩雯 2209 6211 查詢:2209 6280 承印:泰業印刷有限公司 香港新界大埔工業邨大貴街11至13號 發行:青揚書報社有限公司
香港九龍觀塘海濱道143號航天科技中心13樓
影音使團海外分會:
美國影音使團
The Media Evangelism Association (USA) 1613 S. Main Street Suite 105, Milpitas, CA 95035, USA 電話:(1 408) 425 2441
電郵:info_usa@media.org.hk
加拿大影音使團
The Media Evangelism Association 1160-8766 McKim Way, Richmond, BC Canada V6X 4G4 電話:(1 604) 303 9795
電郵:info_ca@media.org.hk
澳洲影音使團
The Media Evangelism Australia Inc. 33/8 Ave of the Americas, Newington NSW 2127, Australia 電話:(61 2) 9648 4447
電郵:info_au@media.org.hk
北京影音使團
北京市朝陽區高碑店.文化藝術新大街1707號.愛德藝術院.四層 馬來西亞影音使團
The Media Evangelism (Malaysia) Bhd. 電郵:info_malaysia@media.org.hk
本刊在 、 、「惠康」超級市場 各大書報攤及基督教書室均有代售
200
www.media.org.hk/magazine
目錄 CONTENTS
本刊文章純屬作者意見,不代表本刊立場。本刊有權拒絕或 修改任何廣告。《天使心》月刊受國際及地區版權法例保障, 未經出版人書面許可,任何圖文不得全部或局部轉載、翻譯 或重印。 JAN 2023 1月號 總幹事序言 《天使心》月刊的祈願 002 攝影為主 感恩頌 004 封面故事 由苦瓜乾到喜樂婆婆 小金子九十載屬天路 006 萬人見證 書畫藝術承傳宣教精神 訪談龍靈光後人龍維欣 014 從「癲賭」人生到靠主得勝重生 張文強 020 巨石強森擺脫內心「朱古力惡魔」! 026 特稿 「兔」氣揚眉 吳宗文牧師 030 使命人生 職業足球員出身的牧師推動福音運動 超過18,000名世界盃球迷擁抱耶穌 036 絲路福音 百年光影,從《倫敦蒙難記》到《生命因祢傳奇》 040 雲彩見證 從「屋邨仔」到創立音樂學院: 上帝才是真正的老闆 柏茵音樂院創辦人
天恩傳奇 當緬甸「古惑仔」遇上天恩宣教中心
幸福學堂
畫中畫 保守你心 常常謝恩
家有一寶 從媒體到餐飲
行哥行傳 願榮耀歸天父!
生活文化 男心女意 平靜安息 072 鐵窗筆語 分別為聖——榮耀上帝 074 大夫在線 血漏的婦人——談中醫治療「崩漏」 076 治強不息 以學習科學的方式在崇拜講道 078 綠色管家 2023年環保能否說好香港故事? 080 心靈解碼 告別憂慮的「4+3」 良方 082 志英理財 從肥媽經歷談2023理財態度 083 思苦後甜 人生常作準備 084 我有話說 快樂的追尋(二十八) 085 還富於文 躺平在主的臨在 086 解毒研究所 總會⋯⋯再見 087 開心快樂人 我是最棒的 088 開心經理人 企業的變革——團隊的擔憂 089 銀齡天使心 喜樂婆婆恩典冊 感謝主,我又回香港了! 090 愛‧閱讀 亞洲基督教史卷一 092 節目精選 097 電視節目表 098
Eddy 046
054
神蹟同行 060 國度角度 中央化與去中央化之爭論 064
066
068
070



總幹事序言 PHOTO / Andy 、Tidus 02 總 今期是本刊第200期出版的時刻,也適逢是喬 宏太太小金子來港的日子。 因着疫情,已有數年未能跟喬媽實體見面,久 別重逢,喬媽雖然巳屆九十高齡,行動不便,但仍 然是處處感恩、充滿喜樂地分享上帝的作為,還記 得二十多年前拍攝福音電影《天使之城》時,我們 曾經說過:如果喬宏叔是天使奇俠,喬媽就是天使 女俠,今次再見到的喬媽的慈祥臉容,更活像一位 從上帝而來、充滿喜樂的天使! 喬媽今次跟我們分享她過往的一些傳福音心 得,就是當她向未信者介紹上帝和耶穌時,他們未 必能即時了解《聖經》中創造天地的真神是怎麼 一回事,但往往講到鬼,他們反而會更容易理解明 白。但基督徒是不應講傳揚鬼的,所以喬媽在傳福 音時有個秘訣,就是分享天使! 天使,可以是在我們身邊出現的好人,在我們 困境中幫助我們的人,就好像上帝為我們差派來的 天使,在我們需要時便會出現。 影音使團過去曾拍攝電視連續劇《天使家族》、 《生命天使》等以天使命名的節目。2006 年本刊創 刊時以「天使心」命名,就是盼望以天使讚美上 帝、榮耀上帝、見證上帝,按上帝的吩咐被差派到 不同的地方實踐使命。 還記得本刊第一期目的是建立一些人生反思的 話題,所以當時以《達文西密碼》這電影引起公眾 的話題,與讀者分享《達文西密碼》中的內容與 符號中,哪些是真實的,哪些是錯誤的,重申耶穌 基督是真實存在,是曾經被釘十字架死亡後三天復 活,我們以雜誌的形式引發公眾話題,再帶出《聖 經》中的真實資料,幫助基督徒朋友藉此向未信的 親友講解福音,可說是一個福音的教材。 我們當時更特別爭取將本刊在各大便利店發 售,也在港鐵站內刊登廣告,期待有更多人能接觸 本刊的封面與內容,以實體的封面進入每個家庭的 茶几上,方便基督徒在家庭聚會時更容易向親友傳 福音。 《天使心》月刊 的 祈願





這些話題好像影音使團33年來製作的內容一 樣,藉時事、名人、藝人等話題將信息帶出來。 我見過以前不少娛樂雜誌,像早年的《螢幕偶 像》,很多人都喜歡看電視劇中的男女主角、當紅 藝人的故事內容,有圖,有相,有秘聞,故此,我 們也盼望在市面上有一份輕鬆但以聖經觀念為主的 雜誌出現,不是充滿艱深的講道資料,而是較軟性 將真善美信望愛的內容帶出。 因此,你會發現本刊的封面都是非常特別的, 曾經在50期有賊王葉繼歡,他在監獄中看見本刊, 知道是一本基督教雜誌,信耶穌後的他,洗心革 面,但已在監獄中半身不遂,但他也要親自寫信給 本刊,盼望告訴人如果生命能重頭再來的話一定要 認識耶穌,被上帝所用,勸戒年輕人不要走歪路, 不要像他為了錢而抱撼終生。 當然,一些離世的朋友,或是經歷不同危難的 人都成為了本刊的封面,好像剛過去一期,我們的 好朋友阿Mo李啟言的爸爸李盛林牧師,我們也將 他的祈禱與信心的經歷成為封面。 未來,我盼望本刊的封面話題會更具吸引力, 同時內容反思主題更多元化,不單局限於演藝名人 為主的封面,無論是天文地理、大自然的創造、科 學發現、哲學反思,甚至是靈界的課題都可以成為 封面話題,當今天很多坊間電視台都以鬼神靈界、 風水算命作節目的招徠時,我們都應在農曆新年期 間以主題內容告訴大家何謂真正的趨吉避凶,甚麼 是蒙福之路。因為《聖經》是一本超時空的書,它 會告訴我們上帝的心意:認識祂,回到祂身邊,跟 祂的旨意而行。只有跟隨耶穌才可走上這條上帝為 人所設的蒙福之路,因耶穌說:「我就是道路、真 理、生命,若不藉着我,沒有人能到父那裏去。」 這樣人才可回到生命的本源、創造的本源。 好像剛成立的「中華聖經文物館」,我們的 目標不是要建立文物館,而是要成為一個訓練的平 台,讓更多人懂得將這些聖經歷史文物活化,讓更 多基督徒懂得分享、傳講。同樣,未來本刊不單是 一本刊物,而是成為訓練基督徒能將當中的話題內 容與人分享。我盼望未來不單是我們的編輯團隊獨 自努力設計具吸引力的話題封面,更希望提供課程 給願意使用這雜誌分享福音的人。我們計劃將本刊 內容新媒體化中,成為不同的多媒體短片在新媒體 中出現,讓本刊封面話題的關鍵字更容易在網絡被 搜尋,讓福音人生反思的話題更廣泛傳播開去。



作者簡介 張瑪莉市場推廣(國際)有限公司執行董事、專業 形象及國際禮儀學會會長、專欄作家及藝術創作者、 RTHK5 「美麗人生」節目主持。自幼酷愛繪畫藝術, 常以照相機描繪世情,足跡遍及各大名城古鎮。所獲 獎項包括:香港小姐冠軍、香港十大傑出青年、十大 愛心之星等。 https://www.marycheung.com 攝影為主 TEXT & PHOTO / 張瑪莉 ART / JL 中國北京‧2018‧「感恩頌」 攝 04
從出生到今天,從沒有到擁有, 從無愛到博愛,從寂寞到欣悅, 從步行到開車,從黑暗到光明, 從無知到明理,從饑餓到飽足, 從失喪到永生,從昨天到今天, 從耶穌基督升天復活到再來; 從絕望到盼望。 人所有的經歷都是一場感恩! 聖誕節就是一個盼望和拯救的開始! 感恩頌 耶穌說:「我是道路、真理、生命。若不藉着我,沒有人能到父那裏去!」 (《約翰福音》14章6節)














06 封面故事 TEXT / Cherry PHOTO / Tidus Andy ART / Andy 小金子 九十載屬天路 由苦瓜乾到喜樂婆婆 封






筆者連要回想昨晚吃過甚麼都感到吃力,年屆 90歲的喬媽卻能輕鬆自如地回憶往事,由她幾歲走 難、年輕時與喬宏叔如何相遇相愛,到她最近宣教的 過程,都能鉅細無遺地娓娓道來,而且說得如流水般 順暢自然,實在叫人驚嘆上帝是何等痛錫和重用這位 僕人,讓年邁的她能夠安心地為主工作。 「讚美主,仍然肯使用我這個老婆婆。」喬媽感 恩地說。 苦瓜乾小女孩 眾所周知喬媽是喜樂婆婆,她不但笑容滿面,更 落力將屬天的喜樂帶給身邊的人,讓他們尋到真正的 快樂。誰知道喬媽的童年過得非常苦,養成小時候的 她長年掛着一張「苦瓜臉」。 「我四歲時媽媽便過身,爸爸再娶但我跟後母關 係不好,並且六七歲便被領養。童年那麼苦,當然沒 有喜樂。」日軍侵華的八年抗戰期間,養父是軍人, 帶着一家跟隨軍隊逃避日軍,勝利後喬媽曾在北京住 了幾年,因此說得一口標準的普通話。上帝的意念高 過我們的意念(《以賽亞書》55章9節),祂編寫 的人生劇本絕非我們所能預料的,而喬媽的故事竟然 因這語言,及上帝所賜的美麗聲音而展開豐盛的新篇 章。後事如何,容筆者稍後分解。 這位老婆婆有一張我們熟悉的慈祥臉孔, 有一把我們一聽便能分辨出聲音的主人的金嗓子; 這個我們熟悉不過的人, 就是「喬媽」小金子。 然而,你知道她差一點就去當修女嗎? 你知道她與喬宏叔婚前曾為信仰而角力嗎? 趁着喬媽90歲大壽的日子, 本刊邀請她分享悠長人生裏經歷的豐富主恩。 抗戰勝利不久又爆國共內戰,養父再攜妻女到 香港避難,怎料逃過戰爭卻逃不過經濟風暴,一時之 間不單房子、汽車都要變賣,喬媽也被逼輟學,當時 她尚欠半年便高中畢業。「童年的遭遇令我快樂不起 來,造成執拗的性格,我不喜歡和人交往,也沒有甚 麼人喜歡我。」喬媽回憶道。 差一步做修女 少女時代的喬媽就讀半山的普通話私校,小息時 同學們三五成群地玩耍,她卻因內心常被愁苦籠罩, 坐在一旁悶悶不樂,羨慕着身邊幾位快樂的女同學。 她解釋說:「我童年不幸福,她們也有難處。我問她 們為甚麼那麼快樂,她們笑着回答:『不用問,你跟 我們回教會便知道了。』原來她們是基督徒。」 「教會?」喬媽一聽到「教會」兩字便耍手擰頭, 同學們再邀請她去參加戲院佈道會,「戲院?我去!」 喬媽笑說。可是她當日對耶穌救恩的信息沒有感動, 「我告訴同學:『你們的信仰很霸道,信者上天堂, 不信的就落地獄!』 無論如何,福音的種子已落在喬媽的心田裏, 慢慢發芽。當喬媽剛到養父母家,想念親人常愁眉苦 臉,養父母以為再多領養一個女孩作伴會改善她的情 緒,怎料連新領養的妹妹很快也變成一張苦瓜臉。 「離開了自己的家庭,哪會開心?」喬媽說。

08 信仰與戀愛角力 是時候揭曉喬媽的語言如何改寫一生了。喬媽輟 學後要找工作幫補家計,雖然她廣東話和英語都不靈 光,但上帝為她預備了一把清脆的聲線,純正的普通 話講得悅耳動聽,不但助她獲得麗的呼聲電台國語播 音員的工作,後來更邂逅了第五代基督徒喬宏叔,帶 她認識真理。 我們認識的喬叔喬嬸恩愛得如膠似漆,但其實兩 人當初是因誤會走在一起。喬媽解釋說:「同事知道 我信耶穌,但他們不懂天主教和基督教的分別。喬宏 也以為我是基督徒便展開追求,後來才發現我是天主 教徒。」 喬宏叔非常愛喬媽,喬媽也深知遇上了萬中無一 的好男人,但信仰的分歧令她對這段愛情卻步。直至 有一天喬宏叔對她說:「我認真喜歡你,將來我離開 世界會回天家,但我不忍心看到你在下面(地獄) 受苦!」這句話深深感動了喬媽,她遂接受喬宏叔的 追求。 愁苦的兩姊妹發現喜樂從信仰而來,遂展開尋找 耶穌之旅。她們留意到般咸道有一所很大很漂亮的教 堂,便約同兩位同學一起按鐘「找耶穌」,開門的是 一位⋯⋯神父。就這樣,她們糊裏糊塗的進了天主教 堂,神父給她們每人一本《要理問答》,讀完後沒讀 《聖經》就受了洗。 「因那時天主教不容許平信徒看《聖經》,只可 聽神父講道理。」受洗當天,神父將四個女孩子分開 作個別問話,問喬媽願意為耶穌獻上甚麼。「我說我 還在讀書,沒錢獻給耶穌,神父笑着說他是問我願不 願意奉獻自己給耶穌,即是做修女!」喬媽笑說當時 自己沒自信,個性又彆扭,「心想將來應該嫁不出 去,做修女也不錯,於是說了『願意』。」 四個女孩子中,只有喬媽一人願意做修女。然而 上帝為她安排了一條截然不同的道路,不久之後她遇 上了一生中的最愛——喬宏叔。







10 問我們為何不能等到天亮才結婚,我們便告訴他我們 的故事。牧師說很欣賞我們對信仰執着,但當晚他不 能為我們證婚!」原來香港法律規定市民只可在上午 9時至下午6時結婚,否則不算合法。當然喬宏叔和 喬媽最終完婚,因結婚時喬宏叔正在拍戲,只得三天 婚假,兩人在禮拜堂行完禮便匆匆換上短褲去銀礦灣 度蜜「日」,開始相濡以沫四十多載。 至愛離世歷悲痛 1999年,喬宏叔在開車途中心臟病發被主接 去。喬媽回想當年喬宏叔打開她心房的那句「不忍心 看到你在下面受苦」,感恩地說:「我們婚後上帝大 大地賜福給我,感謝上帝讓我跟着喬宏佈道,更有機 會在佈道會做翻譯。」 這對深深相愛的男女走在一起,當然有甜蜜溫 馨的時候,但兩人各自執着於自己的信仰,成為了 相處的磨擦、婚姻的攔阻,甚至令他們一度決定分 手。但同時在他們「信仰切磋」的過程裏,喬媽知 道兩個信仰雖信同一位上帝,但天主教信仰裏加了
言。喬媽接着說:「我們兩人真心相愛,各自禱告, 求上帝改變對方。」 半夜三更去結婚 上帝憐憫這對真心相愛的男女,在喬媽的心裏動 工,使她願意認識基督教。有一晚的深夜兩人又為婚 姻問題爭拗,「我衝口而出說:『我願意認識你的信 仰,你還堅持甚麼?』其實我那刻並不是有大感動要 跟他信基督教,但不知怎的說了出來。」 「好!我們現在就去結婚吧!」喬宏叔不理當時 已經零晨12時多,立刻叫醒喬媽父母,但已篤信天 主教的喬媽父母不肯為他們證婚,二人遂半夜三更乘 小艇過海找朋友證婚。說起這段輕狂往事,喬媽不禁 眉開眼笑:「朋友以為我們『做錯事』,悄悄問我 喬宏是否欺負我。當然沒有!他很尊重我,只拖過我 的手。」 他們和朋友到達教堂時已接近天亮,仁慈的牧師 不但邀請他們進教堂,更叫醒師母預備茶點。「牧師
很多人的規定,固執的喬媽仍然不願回轉。 「電台裏有一位弟兄問我哪時和喬宏結婚,我 告訴他我想放棄喬宏。雖然這位弟兄對信仰糊裏糊 塗,但他點醒了我:『現在的教皇說天主教徒不可 跟基督徒結婚,但假如新教皇改說天主教徒可以 和基督徒結婚了,你和喬宏卻已各自嫁娶,那時怎 辦?』對啊!兩教不可通婚的教義是由人定而非上 帝所定的!」還有一次兩人對《聖經》的真確性起 了爭拗,喬宏叔索性找喬媽的神父對質。天主教指 基督教擅改《聖經》,神父卻說不出改了甚麼,反 而喬宏叔能具體指出天主教《要理問答》所刪走的 《聖經》十誡:不可拜偶像的內容,令神父啞口無











喬宏叔去世那晚,他和喬媽在朋友家聚餐後開 車回家,途中心臟病發。「我見他突然大口吸氣, 便知道他心臟不舒服,感恩我懂駕車,立刻把車停 在一邊。」看到失去知覺的丈夫,喬媽不知所措, 奇妙的是上帝預備了一位曾經學醫的年輕朋友尾 隨着他們的車回家,他即時停車打911為喬宏叔求 救,待救護車到場後接手搶救,可惜到達醫院前已 返魂乏術。「後來下車幫忙急救的年輕朋友告訴我, 其實他當時已摸不到喬宏的脈搏,他是沒經歷甚麼 痛苦便返天家了。」 離開醫院,喬媽獨自打開家門,看到丈夫叫她回 家才摺的衣服;上床準備睡覺,但已失去了枕邊人。 「我在床邊痛哭,跪下祈禱說:『祢給我和喬宏有隨 時睡着的恩典,我今晚繼續需要這個恩典,否則明天 我沒精神面對一切。』感謝主,結果我一邊哭一邊 睡,到睜開眼時天已明。」 90歲大壽之謎 喬媽垂垂老矣,卻仍然緊握丈夫傳遞的福音棒, 馬不停蹄跨國為主傳揚福音。喬媽回想當年喬宏叔離 世後第二天她打電話給舉辦佈道會的單位告知消息, 「誰料他們不肯取消聚會,更願意由我補替。」她靈 修時看到亞伯拉罕憑信心走主所安排的未知之路,她 也捉緊上帝的手勇敢起來服侍祂。「重複回憶和分享







在去年12月舉辦的「中華聖經文物館金色聖誕 音樂分享會」中,影音使團創世電視特別向喬媽小金 子頒贈「創世電視因祢傳奇榮譽大獎」,場面感人。 這個獎項特別表揚看重福音價值,將一生委身宣教傳 福音行動,亦因此上帝令他們生命因而傳奇的人。 喬媽多年來傳承喬宏傳福音的使命,從不言休, 今年是喜樂婆婆二十周年記念,同樣是創世電視二十 周年,因此藉喬媽這次來港,特別先頒贈此極具意義 的獎項給她,盼望藉喬媽的見證,將宣教士的使命傳 承給下一代。 12 享我與喬宏的生命見證,是上帝給我的祝福和醫 治。」喬媽說。 在差不多三年的疫情裏,喬媽的福音使命沒 停止過,只是由實體轉到網上而已;隨着近月防 疫政策放鬆,她又憑信心再度為上帝的國度「出 征」,上帝也特別差派天使照顧她,先有黃凱欣 和她一起「遊船河」傳福音,後有美麗傳奇的弟 兄姊妹在三藩市和紐約的佈道旅程全程照顧她, 另有一位弟兄專為她推輪椅。「我已兩年多沒有 外出服侍主,不知道體力能否應付。但每當我祈 禱問上帝的心意後,祂便派遣天使照顧我,況且 我已年邁,是上帝揀選我給我機會為祂工作,我 怎能Say No?」 喬媽在剛過去的11月順利完成在三藩市和紐 約的福音聚會,12 月則去了香港出席影音使團的 福音活動。上帝賜喬媽莫大的福氣,使年屆90歲 的她擁有連年輕人也自愧不如的魄力。 「其實我也不肯定自己是否90歲。我養母說 我1933年出世,因此我的身份證寫着『1933』, 但後來我重遇親生哥哥和姐姐,一個說我該加一 歲,另一個又說還要加一歲,若是正確的,我該 是92歲。」 那⋯⋯我們應否祝賀喬媽90歲大壽好呢? 「哪用理它!只要開心慶祝就對了!哈哈哈 哈!」喬媽大笑着說,這個喜樂婆婆用大大的笑 容,盡顯活在主裏的人是何等快樂。







萬人見證 TEXT / 皓恩 PHOTO / Tidus & 受訪者提供 ART / JL 新會 新 會 人 人, 年幼 熱 熱愛 書畫畫,擅 長繪 繪 畫山 畫 水、 水 人 人物、花 鳥 鳥; 年少 少 年 時歸 歸 時 信基 信 督, 蒙上 蒙 帝 帝呼召成為為牧牧師,後來 後 得到 得 將《 聖 經》 經 融入 書畫 的 的異 象, 以經經、畫畫、 字 字, 透 透過 在紙 上 上和 諧呈 現, 現 領人 人 深思 當中中的的寓意。 龍靈 靈 光 光牧 師留 下 下的 藝術 術 作品 數之 不 盡, 盡 最 最為 獨特 的是 的 是 以聖 聖 經典 典 籍為 題的 書畫畫,如 如 , 《浪 浪 子圖 子 圖 長卷 》、、《天 國和 平圖 圖 》和 和 》 《十 十 童女 女 童 圖長 長 圖 卷》 卷 。早 早 。 前由 聖樂 樂 服 服務 務 社 社主 主 辦的 辦 的 龍靈 光牧 光 師書 畫展 畫 將 將其 其 數十 數 十 年來 來 的 的精 心傑 傑 心 作再 作 次展 次 展 出, 出 而本 而 本 刊有 刊 幸邀 邀 得龍 得 氏後 氏 人— 人 —四 四 子龍 維欣 欣 牧師 牧 師 分享 分 享 父親 父 親 往昔 的點 點 的 滴, 滴 以及 以 他為為後世後世留下的重的重要要影影響響。 萬 14 書畫藝術承傳宣教精神 龍維欣 訪談龍靈光後人





龍靈光牧師一生熱心宣教,竭力傳揚福 音,與同為傳道人的師母育有四子一女,龍 維欣牧師便是家中的四兒子。 「爸爸年紀小小已經可以繪畫大型畫 作,大家都喜歡看他作畫。」龍靈光牧師天 賦異稟,十歲已能獨立畫巨製,眾人皆嘖嘖 稱奇。後來他在美術師範學校學 習,18歲 時蒙恩歸信基督,師範學校畢業後成為一名 教師。「大約三四年後,爸爸蒙上帝呼召, 進入神學院全心裝備。」專心修讀神學的緣 故,龍靈光牧師期後極少執筆寫畫。 及至一天他靈感忽現,假如將《聖經》 之內容以美術、書法來表達,豈不妙哉? 「出於這份感動,爸爸便決心讀經、寫畫、 寫字,將他本來的嗜好混合應用,成為傳福 音的渠道。」龍維欣牧師說。 「我今日所吩咐你的話都要記在心上,也要殷勤教訓你的兒 「我今日所吩咐你的話都要記在心上,也要殷勤教訓你的兒女。 無論你坐在家裏,行在路上,躺下,起來,都要談論。」 (《申命記》6章6-7節) 50年代一家人在印尼。 龍靈光牧師50年代初於香港聖約翰座堂的副堂舉辦畫展。



龍靈光牧師在印尼舉辦畫展為建堂籌款(前排左三)。 龍靈光牧師在印尼畫展上即席揮毫。 以字畫、報刊興旺福音 後來龍靈光牧師有機會到美國深造神學,成為 美中浸信會的宣教士。「爸爸在美國回來,於國內展 開宣教工作,同時不忘繪畫寫字。」直至 1951年由 國內來香港,由於香港初期工作並不忙碌,龍靈光牧 師便按感動舉行畫展。「當時一連三天,在聖約翰副 堂舉行畫展,來欣賞的人有書畫家、教會牧師及基督 徒,大家都對爸爸的書畫予以好評。」龍維欣牧師分 享,當時香港沒甚麼書畫作品的內容是取材自聖經金 句,因此該次畫展為大家留下了深刻印象。 1953年,龍靈光牧師到印尼宣教,在主的帶領 下,他結識了一群基督徒,大家志同道合,便同心在 當地開荒,成立印尼基督教為道堂,並透過畫展為建 堂籌募資金,當時的畫展吸引不少華僑及基督徒來觀 賞。「為道」的意思是為基督作見證,而這名字可 追溯至前一年龍靈光牧師在香港創刊的《為道報》。 「早在1949年,爸爸已在國內辦《恩典報》,希望 透過基督教刊物造就信徒和領人歸主。後來到了香 港,便以新面貌《為道報》與讀者見面。」《為道報》 是雙月刊,創刊45年來蒙上帝恩待,歷盡風雨,經 費卻從無缺欠。「報刊的文章有的是讀者投稿,有的 是爸爸翻譯外國文章,甚至親撰刊文。我小時候經 常幫忙包裝《為道報》,拿到郵局寄至本地和世界各 地。」雖然龍靈光牧師後因退休而停辦《為道報》, 但他當年開荒牧養的基督教為道堂時至今天仍然興旺 繁盛,福音的熱度不曾退減,如今更是印尼為人熟知 的教堂。 在父親耳濡目染之下,龍維欣牧師從小立志事 奉主,他先在美國修讀聲樂和宗教音樂,隨後進深學 指揮,繼而進入神學院接受裝備,回港後曾在香港浸 信會為道堂事奉,期後在宣道會北角堂擔任音樂牧 師,於2002年在宣道會北角堂的分堂(東涌堂)擔 任開荒工作,至數年前退休。「爸爸總是以他的生命 感染身邊的人,對宣教特別熱心,他定意要讓我們做 子女的感受到做傳道人是一件十分喜樂的事情。」龍 維欣牧師直言,踏上音樂宣教的路,父親的啟發不無 影響。 16


恆久禱告成子女榜樣 「爸爸那一代其實經歷了很多風浪,但他依然忠 心信靠上帝。」當年龍靈光牧師一家逃難到香港, 龍牧師要照顧同行的外籍女宣教士,而龍師母則左右 手各拉着大兒子和二兒子,身後背着三兒子走在人群 中。當時走難的人如潮水洶湧,不少家庭都走散了。 但環境越危險艱辛,他們則憑信心越加倚靠上帝,越 經歷上帝奇妙的恩典,四兒子龍維欣和排行第五的妹 妹則生於相對平穩的年代。 談及兒時的回憶,龍維欣牧師分享他最難忘的是 父母每天禱告的習慣。「小時候,有時我們經過爸媽 的房間,會偶然聽到他們正在專心致志為我們眾兄妹 祈禱,他們常常透過禱告,求天父上帝的恩手眷顧孩 子。」龍維欣牧師至今回想,內心依然非常感動,父 母豐滿的愛、以基督為首的價值觀成為他們的榜樣, 使他們在聖經真理中長大。 除了為家庭祈禱,父母也恆常為教會、弟兄姊 妹祈禱。「他們每天都會花一段時間禱告親近上帝, 爸爸身為牧者,其實他很忙碌,但他仍努力盡上父親 的本分。」只要有時間,龍靈光牧師便會帶兒女去游 泳、看足球,這些片段也是龍維欣牧師快樂的童年回 憶之一。「爸爸總不忘記關心我們,並鼓勵我們多看 看這個世界。」 每逢龍靈光牧師到國外宣教,長時間不在家,母 親這時便擔起教育的角色,用《聖經》的話語教導 子女,為他們樹立信心的好榜樣。「爸爸媽媽經常說 兒女是上帝所托管的,是上帝給他們的職分,他們要 做的是為主培養合用的器皿。因此父母對我們的影響 是強烈的,使我們至今沒有偏離正路。」龍維欣牧師 滿懷感恩地說。 「我今日所吩咐你的話都要記在心上,也要殷勤 教訓你的兒女。無論你坐在家裏,行在路上,躺下, 起來,都要談論。」(《申命記》6章6-7節)正如 摩西昔日對以色列民的一番勸誡,龍靈光牧師和師母 同樣遵循上帝的教誨,仿效耶穌基督的榜樣,用真理 龍靈光牧師、師母遊山玩水。 濟濟一堂的全家福,最前排為龍靈光牧師、師母。




龍靈光牧師與妻子結婚多年,感情甚篤。 《八十鯉魚圖》 牧養小孩。在主裏教養得宜的緣故,龍靈光牧師膝下 四子一女長大後均成為上帝合用的器皿,在各個範疇 盡心事奉主——長子龍維耐醫生,在多國參與醫療宣 教工作;二子龍維堅先生,為美國一華人教會的執事 和義務傳道;三子龍維忠先生,乃香港播道神學院榮 休教授;四子龍維欣牧師為音樂牧師;五女龍維安女 士,曾在美國一教會的幼稚園任院長多年,並常在教 會聖樂上事奉。 主的恩典夠用 龍靈光牧師於在世最後幾年曾患中風,四肢活 動能力尚存,但說話能力則有所影響。即使是這樣, 上帝依然給他有力量在教會事奉,而他 也不忘提筆作畫,記錄主的厚恩。「爸 爸生病後的畫作,達到了一個全新的境 界,他的創意和靈感更豐富,筆觸還如 往日的靈活有力。」訪問當天,龍維欣 牧師領筆者欣賞一幅山水畫,是龍靈光 牧師到張家界遊玩後的靈感之作,簡單 的濃墨勾勒出山巒起伏的輪廓與暮色, 讓人一眼就認出是張家界之景。 龍靈光牧師一生所好以畫為首,詩次之,最喜 歡漢碑書法。問及龍維欣牧師最喜歡父親哪幅畫作, 他表示每幅字畫都是佳作,而最獨特的非《八十鯉 魚圖》莫屬,畫中有80條栩栩如生的鯉魚,形態不 一、動靜自如,甚為賞心悅目。「這是爸爸在80歲 大壽時的作品,他為家庭、為上帝所賜的年日感恩而 作畫,祈願每時每刻都滿有喜樂。」80條鯉魚寓意 如魚得水、恩上加恩,不說不知道,原來畫內還有玄 妙之處。「若然你細心數算,會發現畫中其實有82 條魚,說不定爸爸是希望表達『八十有餘』的意思 吧!」 18



龍靈光牧師獲美國浸信會西北神學院頒發榮譽道學博士學位。 印尼畫展。 龍維欣牧師認為上帝的道是活潑的,福音是全 面性的,不論是書畫或音樂,無所不能的上帝總能透 過人的五官,以任何形式、途徑讓人認識真道。「爸 爸除了較擅長書畫,其實音樂方面也有涉獵,他在美 國攻讀神學時曾學拉小提琴,回國時除了小提琴,也 帶了一支喇叭回來,後來也曾為教會作曲填詞,雖產 量不多,但總有所為。」龍靈光牧師一生遵行主道, 不但善用上帝所賜的藝術才華,更蒙主祝福,生養眾 多,兒孫滿堂,家族忠心事主,就如詩人大衛在《詩 篇》128篇所說:「凡敬畏耶和華、遵行祂道的人便 為有福!你要吃勞碌得來的;你要享福,事情順利。 你妻子在你的內室,好像多結果子的葡萄樹;你兒女 圍繞你的桌子,好像橄欖栽子。」 遵行主道的人是蒙福的! 除了在香港和印尼舉辦畫展,龍靈光牧師的書畫 曾於世界各地展出,包括曼谷、新加坡、英國、美國 各州大學,每場展出都深受好 評。1999年,龍靈光 牧師安返天家,遺下的畫作一直存於居所。「當我們 看到這些書畫時,總覺得父親很有恩賜,並希望讓更 多人知道,因此最近舉辦了展覽,盼望與弟兄姊妹一 同欣賞,將榮耀歸給天父。」 龍靈光牧師以唯妙唯肖的書畫傳福音,畢生盡 心竭力領人歸主,讓人不期然想起百多年前,多位宣 教士遠道來華傳福音的堅毅精神,而其中一種方式便 是福音畫報,兩者均以引人注目的畫作,帶出福音信 息,簡單直接令人留下印象。

































萬人見證 TEXT / 皓恩 PHOTO / Tidus & 受訪者提供 ART / JL 30 0 年, 年 年輕 時本 平 平步 青雲,卻 染上 染 賭癮 無法 自拔,在 賭海 浮 浮 沉 沉數 十載,及 至他 至 遇見 見 上 帝, 靠主 的奇 的 妙大 能終 能 脫離 離 纏 擾多年的惡習 惡 ;洗心心革面後努力 工作,卻 在事 業如 日方 日 中之 之 時 患 上 癌症,在 五年 內經 內 歷26個 周期 期 化療 也不 也 怨天 尤 尤人,反 反 以 耶穌基督的的十架為榜榜樣。「 我們 何 時 軟弱, 衪 就使 我 我們 變得 得 剛 強!」憑着堅 着 定的信心 信 ,他最終 靠主跨勝,成 , 為逆轉的 轉 奇蹟。 從「癲賭」人生到 靠主得勝重生 張文強 萬 20




















眼前的Frank 一身正氣,讓人難以 想像他從前是一名病態賭徒,一星期七天在 賭博時忘我的樣子。「貪財是萬惡之根。有人 貪戀錢財,就被引誘離了真道,用許多愁苦把自己 刺透了。」(《提摩太前書》6章10節)「這節經文所 形容的,正是我當時瘋狂賭博的寫照。」Frank說。 賭博使人理性盡失 「小時候曾聽媽媽說,一位做生意的長輩嘲笑我們這輩子都不 會有出頭天,這件事我一直記在心 中。」Frank 生於基層家庭, 父親要勤勞工作才能養活一家五口,而長輩的嘲諷使 Frank認 為金錢就是一切。「後來在中學經常看到有人賭馬贏得巨 額獎金的報導,我便覺得這是合法的致富途徑。」在金錢 掛帥的價值觀下,再加上從小觀察親友打麻將的技巧, Frank 在中學已開始與同學打麻將及賭馬,用僅有的零 用錢作為賭本。 「大專畢業後,我考上公務員職位,收入不 錯,然而我不滿足,經常幻想自己會升官發財。」 單靠一份收入無法滿足 Frank 對成功的定義, 1989 年他趁樓價下跌投機置業,兩年後樓價倍 升,賺了五十多萬。「我以為自己有運氣,有膽 識,找到結合興趣的致富方法,於是學人炒外 匯,自以為眼光獨到,卻輸光賺來的錢。」 但Frank不甘心,盤算如何把輸掉的錢贏回 來,他曾經在馬場以小博大,一天內花幾百元贏 來20萬,導致他以為買得大便會贏得大,最終投 注額幾何級數增加。「我有一個信念:在哪裏跌 倒,在那裏站起來。在賭場輸錢,就要在賭場贏 回來。」為了「收復失地」,Frank 同時向三四家 銀行借貸,他視貸款如同自己的錢,在賭輸光後繼續 借,到最後形成「侷賭」心態。「因為欠下的金額太 大,只能以賭還賭,慢慢陷入賭、輸、借、還的漩渦。」 這個惡性循環持續了十多年,期間他還因金錢爭拗與太太 離婚。







蒙主拯救 脫離賭海 2002年,Frank的信用卡債項高達50萬,即使工 作收入不錯,也令他入不敷支。「實在沒辦法,我只 好向家人求助,家人得知後既愕然又傷心,不敢相信 我是病態賭徒。」為了讓家人代還卡 數,Frank謊稱 自己若破產便會失去工作和大好前途,又在家人面前 發誓不再賭博。 當時妹妹邀請 Frank回教會,希望耶穌能幫助 他,出於人情債的緣故,他姑且答應,在教會隨便答 應了決志。「我確實停止賭博幾個月,但卻是陽奉 陰違,其實沒有處理賭癮的問題。當家 人幫我清還卡數後,我很快故態復 萌。」每當Frank 想到身邊的朋 友有車有樓,自己一無所有之 餘還欠下一身債時,便會感到 不值,認為彼此的差距就在於 一個翻身的機會。 「於是賭馬、賭波、過大 海,重新佔據我整個生活,我可 以一天輸掉一個月的薪金,很快又 欠下過百萬的債務,卻不敢再向家人求 助。」身在教會,心在賭 場,Frank 坦言雙面 人的生活非常痛苦,既要隱瞞自己的賭博行為,違背 對家人的承諾;又要為晉升而辛勤工作,同時為賭債 賭本天天跑數,疲憊的他甚至在路經天橋時閃過自殺 的念頭,殊不知原來上帝為他預備了一個更美好的翻 身機會。 「我父母原本信奉民間信仰,初一十五會到廟宇 拜祭,但在我承認自己有賭博問題後,他們在一次佈 道會上決志信主,並且每天為我禱告,盼望主耶穌來 拯救我。」在父母恆切的禱告 下,Frank 有一天在房 間找到妹妹兩年前寫的信,心靈被信中一句經文觸 動:「耶穌又對眾人說:我是世界的光。跟從我的, 就不在黑暗裏走,必要得着生命的光。」(《約翰福 音》8章12節)「那一刻,我反思自己一敗塗地的人 生,便痛哭得很厲害,躺在床上第一次真誠地向主禱 告:『主,祢若是真實的,求祢幫助我脫離賭博 的捆綁』。」 Frank想不到 那次禱告後,他的 生命漸漸出現奇蹟的改變。得到教 會朋友的幫 忙,2004年中Frank到 基督教戒賭中心接受輔導,並刻意 遠離賭博資訊,以前常讀的波經 馬經,在立志戒賭後換成了《聖 經》。「許多人一開始都不相信我賭 了30年,可以一下子完全停止賭博, 但藉着主給我的奇妙力量,我真的脫離了 賭博的魔爪。」戒賭後 Frank 重新出發,花了一 年多便將信用卡債項還清,無需再提心吊膽過日子, 他更在戒賭中心成為義工,以過來人身份勉勵戒賭者 脫癮。「我也與家人重修舊好,重拾美好的家庭時 光,這些關係比從賭博而得的金錢還寶貴。」 博幾個月但卻是陽奉 問 題。當 家 故 態 復 朋 之 大 可 快 又 向家人求 Frank 坦言 雙面 告:『主,祢 的捆綁 生 會 馬 經 了3 但藉 着 主 賭博 的魔 爪。 22 Frank與母親、妹妹合照。 2015年Frank與妹妹 一起在教會受浸。







何時軟弱 何時剛強 雖然Frank 曾因債務而影響升職,但靠着上帝的 恩典踏實工作,備受上司欣賞,從 2009到2012年, 三年內升了兩次職,期間他也得到多次往外地進修的 機會。除了工作受賞 識,Frank 也收獲了上帝所賜的 伴侶,在戒賭中心結識了太太。「當時她陪一位姊妹 上來中心了解戒賭的事情,我們因此而認識。」 然而就如電影情節一樣,當 Frank 的人生漸上軌 道,事業登上高峰期時,卻意外發現患上多發性骨髓 瘤(血癌的一種))。「還記得2012 年我被部門派往 美國進修,短短兩個月竟然瘦了十磅,而且經常感冒 咳嗽,渾身疼痛,回來檢查後便發現患上血癌。」得 悉噩耗的一 刻,Frank 和太太仿如晴天霹靂。血癌通 常被形容為絕症,而骨髓瘤復發率極高,只有少於 10%的人能完全痊癒。「上帝是一位幽默的主,祂讓 我生命轉回,給我好的伴侶,工作漸有成就時,卻又 容讓疾病臨到我身上。」 由2013至2017年,長達五年的抗癌過程中, Frank經歷了26 個周期化療,以及兩次自體骨髓移 植。高劑量的化療藥使他反胃嘔吐、口腔腫脹、腹 瀉,以致情緒不穩,然而太太不辭勞苦,每天早晚來 醫院陪伴,默默守在床邊。「太太如同上帝派來的天 使,她的陪伴給我很大安慰,我也一直求問上帝, 究竟祂要我在這場病患中學會甚麼?」訪談期間, Frank從 不埋怨上帝,反而順服主的引領,憑信心面 對治療。「上帝要我學會放手。信主後,我的舊我仍 在,我依然會想抓住世俗的名利權力,但在病危痛苦 中,當自己無法掌控生命時,金錢權力又與我有何益 處呢?我只能把醫治的主權完全交給主。」 骨髓瘤患者平均的生存時間是三至五年,而 Frank自2013年確診至今,已是 第十個年頭,遠遠超 出醫學數據統計。「這場仗不是單靠自己便能得勝, 而是上帝帶領我打過一場又一場仗,雖然多年來治療 沒有停過,但我不再感到害怕了,因為有主同在,還 有家人和弟兄姊妹的代禱,使我有力量走下去。」今 天的Frank 臉上愁容不再,從容笑對病情,一如保羅 在《哥林多後書》12章9節所說:「祂對我說:我的 恩典夠你用的,因為我的能力是在人的軟弱上顯得完 全。所以,我更喜歡誇自己的軟弱,好叫基督的能力 覆庇我。」 Frank與太太感情穩定,在主裏彼此相愛。 Frank與太太及其父母。 在醫院治療期間,太太風 雨不改陪伴着Frank。 病困中靠主樂觀面對。


終生靠主得勝 榮耀主名 「耶和華說:我知道我向你們所懷的意念是賜平 安的意念,不是降災禍的意念,要叫你們末後有指 望。你們要呼求我,禱告我,我就應允你們。」(《耶 利米書》29章11-12節)如今Frank度過的每一天全 是主的恩典,他更加珍惜眼前人,把握機會為主作見 證。「這是我和太太很喜歡的金句,縱然我的人生如 坐過山車,經歷大起大跌,但感謝主我仍能講見證、 唱詩歌、傳福音。」 「我們在一切患難中,祂就安慰 我們,叫我們能用上帝所賜的安慰 去安慰那遭各樣患難的人。」 (《哥林多後書》1章4節) 「大病一場後,我才真正了解病人原來有許多困 難、需要,若有同路人互相扶持、分享、交流,患者 會比較安 心。」Frank 除了定期回到戒賭中心幫助賭 徒用福音戒賭外,早前他與一群志同道合的病友成立 病友組織,常關心新確診的癌症病人,並進行探訪工 作,三年前他更加入了香港骨髓移植復康會,擔任義 務委員至今。「在過去十年,畢竟我嘗試過幾種不同 的藥,也面對過不同治療,相信我的經歷多少可以安 慰及鼓勵同路人,排解他們的擔憂與不安。」 24 在不同場合上向人分享得救見證。 與病友分享抗癌經歷。




















談及難忘的探訪回 憶,Frank 分享有一 次與幾位基督徒同事探訪一位同事的父親, 他是末期癌症病人。「我們圍着病床唱詩、 讀經、分享,那父親也一起哼唱詩歌,更主 動開口祈禱,將生命再次交托給主。一星期 後,那位父親離世,而該次探訪成為了同事 及時的安 慰。」Frank 從中深深體會到關愛 的重要,因此他在五年前提早退休,撥出更 多時間作關顧探訪及生命分享的服侍。 昔日Frank 曾經深陷賭癮,回轉後在事 業黃金期患上復發率極高的癌症,跌宕起伏 中卻毫無畏懼,深信在上帝沒有難成的事, 被上帝使用至今!從靠財得勝到靠主得勝, Frank 所經歷的是全能上帝的拯救與醫治。 「我現時每天還要服食標靶藥,但感謝主讓 我有精神、健康、安穩的生活,我不知道自 己的生命有多長,但我不再害怕死亡,因為 我相信總有一天我與我的家人會在天家與主 相聚。主耶穌是我一生最美的祝福,盼望大 家都能抓緊這上好的福分。」 家庭照。





萬人見證 TEXT / 陳文怡 PHOTO / 互聯網 ART / JL 萬 26









巨石強森擺脫內心 「朱古力惡魔」! 自承年少常去7-11偷零食 如今見證悔改帶來祝福力量 巨石強森最近在他的 Instagram 上發文透 露他在夏威夷長大,並且全家人住在那裏時, 他的家庭是如何分崩離析的。他也承認14歲 時,幾乎每天都會從當地的一家7-11,偷走一 條士力架(Snickers)朱古力棒作為零食。 後來巨石強森每次開車經 過7-11時,都 會想起自己年少時犯下的錯誤;足見這些小小 的偷竊行為,已經在他心裏留下難以抹滅的印 記。 最後,聖靈感動巨石強森,他似乎再也無 法忽視這項過錯。於是他做了一件事,希望能 擺脫這些年間「朱古力惡魔」在他心裏所造 成的罪惡感。 巨石強森回到夏威夷,並走進當年他行竊 的7-11,買下店裏所有的士力架朱古力棒作為 謝罪。這麼做是為了糾正過去犯下的錯誤,但 此舉僅僅是他悔改的行動之一。 隨後經由聖靈的引導,巨石強森還主動邀 請店裏的每位顧客,拿出他們買的所有商品, 他再自掏腰包為這些人買單。 巨石 巨石強森回到14歲時偷了朱古力棒、位於夏威夷的7-11。 (圖/翻攝自IG@therock)









贖罪之舉讓他人獲得祝福 對某些人來說,這只不過是來自一位有望 成為億萬富翁的人,一項微不足道的善舉。可 是對那些在便利商店,因此得到點心、餐食, 或者是飲料的人來說,巨石強森這麼做,卻為 他們開啟了一扇被祝福的門。 上帝不僅會使用被聖靈充滿、被油膏抹 等蒙受神恩的基督徒,來完成祂的旨意;上帝 也會藉由不合格又有缺點的基督徒,來完成祂 的旨意。巨石強森這個贖罪小善舉所花費的金 額,總計298美元,不論金額多寡,都給當時 受他幫助的人帶來喜樂。除此之外,巨石強森 還給為所有商品結帳的收銀員一筆小費,雖然 不清楚這名得到傳奇名人意外驚喜的年輕人生 活狀況如何。 但是上帝知道這些人的經濟狀況如何。夏 威夷的貧富差距相當大,大多數會 在7-11購物 的人,不是因為他們有錢,而是因為他們能負 擔而且購物方便。 店內架上的士力架朱古力棒全部被巨石強森買光。 (圖/翻攝自IG@therock) 28 巨石強森買下店內所有的士力架朱古力棒。 (圖/翻攝自IG@therock)








行為比言語更具分量 倘若有人詢問當天在夏威夷那 家7-11的顧客,那時發生在他們 身上的事,是否可以說是件好事? 從他們的反應就可以看出,他們覺 得「沒錯,這是件好事」。況且 《聖經》也一再闡述「各樣美善的 恩賜和各樣全備的賞賜都是從上頭 來的,從眾光之父那裏降下來的, 在祂並沒有改變,也沒有轉動的影 兒。」(《雅各書》1章17節) 但是強森這項舉動也展現出, 身為基督徒,都應該要檢視自己是 否有惻隱之心。 經常我們看到名人獲獎時,會簡短地表 達他們對上帝的感謝,或者公開說自己篤信上 帝。不過和他們所說的話相比,他們表現出來 的行為,卻更具分量。多年來,強森早已公開 承認自己篤信上帝。即使他在眾目睽睽之下, 偶爾衝口說出罵人的話,然而他的行動,卻清 楚表明了他的內心。 因此,即使我們幾乎不可能說強森是個完 美的人,但所謂的基督徒,是不是指那些能在 精神上敏銳領會聖靈活動,並將祝福帶給需要 者的人呢?事情看起來確實如此。這些人就是 上帝完成祂的意旨所需要的人:願意依循祂的 旨意行事的人。 。 巨石強森與結帳的店員(左)及其同事合照,並給了一筆小費。 (資料來源:Charisma News,轉載自 4493期《基督教論壇報》,官網連 結: https://ct.org.tw/html/news/)












特稿 TEXT / 吳宗文牧師 PHOTO / Andy ART / JL 吳宗文牧師 特 30









兔,好像其他動物一樣,有很多資料,今年 我想從下列幾個角度來作思想:一)動物中的兔; 二)文化中的兔;三)《聖經》中的兔。 1. 長耳朵——敏於神聲音 兔作為動物有很多特徵,最顯眼的就是牠那對長 耳朵,這代表牠的聽覺很靈敏,亦代表我們基督徒要 敏於上帝的聲音。屬靈的經歷未必是很強烈、很明顯 的信息;屬靈的領受可以在早上逼巴士或坐地鐵,闔 上眼睛默想時,上帝便將一個微小的聲音傳達給你, 告訴你今天要做甚麼,或告訴你今年要做甚麼。 2. 長牙齒——常咀嚼神道 兔的第二個體徵就是有一對過長的門牙,便於啃 吃紅蘿蔔,原來兔那對門牙是會不斷生長,故此牠經 常要啃咬硬東西來調節牙齒的長度,否則門牙便會長 到遮着自己的口,吃不到東西。這個特徵提醒我們要 常咀嚼上帝的話語,晝夜思想。 3. 紅眼睛——別昏暗嫉妒 兔還有另一個特徵,就是紅眼睛。原來白兔 眼球的微絲血管非常多,所以在白毛的襯托下, 看上去就像行桃花運一樣,有粉紅色的眼睛。其 實這只不過是那些特別白的毛跟牠眼睛的微絲血 管拼在一起,就凸顯出紅眼睛出來。兔的耳朵雖 然靈敏,但視力卻很弱。這讓我們看見,如果屬 靈的眼睛看得不清楚且昏花的話,全身就會黑暗 (《馬太福音》6章23節)。





1. 由「陰柔」變為「溫順」 兔是陰柔的代表,但我們不需要「陰柔」,我們需要的是「溫 柔」。所以兔年你想行「運」的話,第一就要操練溫柔。當你以恩 慈待人時,你便能從關係的張力和困境中走出來。 2. 由「狡黠」變為「智慧」 今年如果你要行「運」,《箴言》3章給了我們一個很重要的 應許,就是如果你尋求從上帝而來的真正聰慧,《聖經》說:「這 人便為有福。因為得智慧勝過得銀子,其利益強如精金,比珍珠寶 貴;你一切所喜愛的,都不足與比較。他右手有長壽,左手有富 貴。他的道是安樂;他的路全是平安。他與持守他的作生命樹;持 定他的,俱各有福。」(《箴言》3章13-18節)持守這種智慧的人, 就能夠像生命樹一樣,獲得生命。 32


3. 由「好動」變為「安靜」 兔還有一個特徵,就是好動。香港生活的節奏非 常繁忙,人們心裏常會煩躁,連芝麻綠豆的事也會令 我們感到不安。安靜就是讓上帝有機會和有空間在我 們的生命裏,主動地作工。 4. 由「驕傲」變為「謙卑」 《伊索寓言》中「龜兔競賽」的故事,就是講 兔子很聰明敏捷,牠跑到將近終點時,烏龜仍然在起 步點慢慢地爬,於是兔子便驕傲、輕敵,停下來去睡 覺,誰不知烏龜就在兔子睡覺的時候,越過牠而爬到 終點。人生的成功不在乎你有五千両的恩賜,或勝在 起跑線;而是在乎縱然只有一千両,仍然願意拿出 來運用,且在賽程中持之以恆地穩步前行。因為上帝 阻擋驕傲的人,賜恩給謙卑的人(《雅各書》4章6 節)。 5. 由「敵對」變為「和好」 很多兇悍的野獸,包括人類在內,都喜歡 獵食像兔這樣善良、柔順的動物。試看歷代的帝 王,如漢高祖劉邦和明太祖朱元璋,能夠與他們 共患難容易,但當名成利就時,要與他們共享功 勛就不容易了,很多功臣此時都會被誅殺。所以 我們不單要去消解人性裏的嫉妒和仇恨,也要建 立人與人之間的互信和共享精神。
的預表來到新約時,已經被基督的實體所取代和潔淨了。我們不再是吃甚麼或不吃 甚麼,以致我們能夠進入上帝的國。主耶穌說:「入口的不能污穢人,出口的乃能 污穢人。」(《馬太福音》15章11節)保羅亦說:「凡市上所賣的,你們只管吃, 不要為良心的緣故問甚麼話,因為地和其中所充滿的都屬乎主。」(《哥林多前書》 10章25-26節)只要你祈禱祝謝後,凡可吃的都可以吃。




2.

1. 兔的啟示 《聖經》中的兔又有甚麼啟示,以致我們可以得着教訓呢?《聖經》(和合 本)中只有兩節經文講到兔(《利未記》11章6節、《申命記》14章7節),就 是講到兔的不潔淨和不能吃。那麼還有甚麼教訓呢?難道就是不可吃兔肉這麼簡單
嗎?這也是對的,因為沙士之後,吃野味是很容易感染病毒的。其實舊約食物條例
類間的一種細小及罕見的動物。沙番除了不能吃外,最特別的地方是在《詩篇》 104 篇和《箴言》30 章裏,都說及牠的聰明。沙番知道自己弱小的缺陷,但牠聰 明之處,在於將自己棲身之處隱藏在磐石的縫隙間。耶穌基督告訴我們,凡聽見主 的話就去行的人,好比一個聰明人將房子建造在磐石上,風吹雨淋,房子總不倒 塌;但那些聽見主的話,不肯去實踐的人,則好比一個愚昧人,將房子建造在沙土 上(《馬太福音》7章26節)。 求主今年叫我們能從兔子和沙番身上學得屬靈的功課,真正能「吐氣揚眉」, 將虎年一切的不順景、不如意都洗刷去,在新的一年,憑着上帝藉兔給我們的提 示,蒙恩蒙福! 本文節錄於《「兔」氣揚眉》──兔年的動物講章。 34
沙番的屬靈教訓 當你仔細尋找,《聖經》還有另一種類似兔的小動物,叫做沙番。原來沙番 (Shaphan hare )這名字是按舊約希伯來文音譯過來的,牠是一種介乎鼠類與兔










使命人生 TEXT / 蘇嘉俐 PHOTO / 互聯網 ART / JL 傑西.布萊德利目前是華盛頓州奧本市恩典社 區教會(Grace Community Church)的主任牧師。 他在接受《 Faithwire 》採訪時表示,自從兩年前他 發起福音運動之後,他已經看到成千上萬的足球迷接 受了耶穌基督。 職業足球員出身的牧師 世 界盃 足 球 賽 吸引全 球 球 迷 的關注,而 曾 經是 職業足球運動員的牧 師 傑西.布萊 德 利(Jesse Bradly ),也正透過數位 傳播的方式,向世界盃 球 迷傳揚福音。 超過18,000名世界盃 使用科技傳福音追蹤決志者 「我們透過數位內容來宣講上帝的福音;我在社 群媒體上分享我的故事,觀眾隨後決定是否要跟隨耶 穌。」布萊德利牧師說。「我們接觸到了數百萬人, 有超過18,000人已經決志信主。」 這項福音事工除了邀請人決志,還包括一項門 徒訓練事工。布萊德利牧師與一家運用科技來傳播福 音的全球媒體外展公司( Global Media Outreach) 使 36



推動福音運動 球迷擁抱耶穌 職業足球員出身的傑西.布萊德利牧師。 (圖/翻攝自adammendler.com) 合作,以確保決志者與基督教社群保持聯繫。「外 展公司持續追蹤決志者,我們再幫助決志者找到教 會。」他說。「所以,他們不僅是決志,還能繼續作 門徒。」 布萊德利牧師指出,福音運動的推展出現驚人的 成果,說明「現在全世界對上帝、希望、信仰和耶 穌,都有強烈的渴求與興趣。」布萊德利牧師和他的 團隊嘗試以獨特的方式,在媒體上講述他個人 的故事,並且利用個人的見證,在人們對足球 的興趣與耶穌之間,搭起一座橋梁。 足球員生涯學到的四大教訓 他坦言,在足球員生涯中學到的 最好教訓是,足球確實是一個學習生活 的平台和課堂,可以歸納出幾個重要主 題:一)合作——球隊要想贏得冠軍,最 重要的認知是「我們」比「我」更重要。 二)明確溝通——如果我作為守門員不說 話,球隊的防守就不成形,並讓對手踢進 更多的球。三)共同目標——每個人都需 要朝着同一個方向奔跑,共同分享激情 和承諾。必要的犧牲是值得的。四) 團體意識——球員不論是在球場上、 更衣室或家中都要相互聯繫。在這 種文化中,可以互相激發出最好 的一面,互相檢討表現,並且 經常開懷大笑。 然而,「我們都知 道我們需要比足球更重 要的東西。那就是,當 我們發現自己與上帝的 關係時,我們會在平安 中得到喜樂。我是後來 自己發現了它,靈魂也因 此得到滿足。」


觀眾手機端接收世界盃和福音信息 布萊德利牧師的數位化宣教運動,是在網絡和社 群媒體上創造吸引人的內容,藉此來「引發對話,甚 至讓人轉化」;並且將信息傳送至個人手機端。觀眾 接收到信息後,會先看到一段不到60秒的世界盃足 球賽相關影片,再接着觀看布萊德利牧師宣講的福音 和見證。 布萊德利牧師說:「當你跟他人分享自己的生 命故事時,會更加了解上帝和感恩。我們會看到上帝 如何做工,以及祂如何改變我們的生命。」他繼續說 道:「我們所傳的是從世俗導向心靈層面,然後走向 耶穌的福音。」 布萊德利牧師曾經是一名職業足球運動員,在美 國、蘇格蘭和非洲辛巴威的足球隊擔任守門員。然而 他的職涯悲劇引起了觀眾的關注。 布萊德利牧師在美國明尼蘇達州長大,當一名 職業足球運動員是他兒時的夢想。大學畢業後,他加 入海外職業足球隊。當在辛巴威的足球隊踢球時,他 每周服用處方藥來預防瘧疾;想不到過了一個賽季之 後,藥物的毒性累積在他體內,侵犯他的身體系統, 導致他的心臟出現嚴重問題,同時造成心理影響,包 括一波又一波的抑鬱和驚恐發作。 「當時我為自己的生命搏鬥了一整年,而且10 年後才完全康復。」他說。然而,「在痛苦之中, 上帝孕育了我的新目標和熱情。」他表示,在此人生 的低潮期,「我的身份轉變了,不再因為球場上的成 績表現,讓我在驕傲與恥辱之間患得患失。堅定不移 的感恩,成為我日常生活的一部分。因為無論情況如 何,我每天都可以發現10件最值得感恩的事情。我 在與上帝的真實關係中,得到了力量和醫治。因此我 相信,生活中最好的經歷,可以從最糟糕的情況中產 生。」 38 布萊德利牧師從球場走上教會講台。 (圖/翻攝自FB@jessebradley) 布萊德利牧師推動數位化宣教運動,在網絡和社群媒體上創造吸引人的內容。 (圖/翻攝自jessejbradley.org)








布萊德利牧師在見證影片中分享了自己信主的歷 程。他說,兒時他並沒有信仰,但當他就讀達特茅斯 大學(Dartmouth College)時,修讀了一門「世界 宗教」課程,在課堂上他初次閱讀了《聖經》。「當 時我們研讀了許多宗教哲學,但《聖經》是我認為 在當中最獨特的。」他表示。「在我大二的時候, 我決定把我的生命交給耶穌。那是我與上帝關係的開 始,祂徹底改變了我,包括我的人生以及我與他人的 關係。」 每天都發現十件感恩的事 由於在辛巴威病倒,布萊德利牧師的足球生涯 被迫結束。他說:「我想踢足球踢到40歲的夢想破 滅了,但上帝通過這次考驗改變了我。當我失去夢想 時,我為自己的身份陷入掙扎;我不得不問自己: 『我是誰?我還有甚麼?』後來我明白我仍然擁有上 帝的愛。接着,上帝開始醫治我,並指引我去做義工 和服侍。」 談到職業足球員生涯,布萊德利牧師表示,大 部分人很難想像職業運動員的生活,以及他們在賽場 內外如何成長。他說:「直到現在,我仍然經常 想起過去參賽的情形,甚至在夢中也會出現過去 我沒能成功擋下進球的畫面。我必需學習放下自己。 在球衣和光榮戰績的包裝底下,其實常是一個脆弱的 『戰士』。許多職業運動員不確定職業生涯結束後該 做甚麼,以及如何填補生活的空白。」 布萊德利牧師身體恢復健康之後,毫不猶豫地投 入福音事工,他不再眷戀過往的足球員生涯。他開始 向個人和全球無數的人傳播希望,他的身份變成演說 家、作家、牧師、電台主持人、內容創作者和職場領 袖,這些都是與人連結並改變更多人的簡單方式。對 此,他對上帝的帶領充滿感激之情。 過去兩年傳福音果效勝過前20年 他說:「我們的造物主是仁慈的,祂會用恩典 和慈愛來引導我們,讓我們進入合適的角色,或是一 個特定的位置,因為祂知道甚麼最終對我們是最好 的。」 對於他所推廣的福音運動受到熱烈的迴響,布萊 德利牧師深受鼓舞。他形容自己感到「非常充實」。 他說:「我投入福音事工已有20年了,但我們從未 有像過去兩年來如此豐碩的成果。」 布萊德利牧師在世足賽期間領人歸主。 (圖/翻攝自FB@jessebradley) (資料來源:CBN News,Adammendler,City Gospel Movements, 轉 載自4494期《 基督教論壇報》,官網 連結: https://ct.org.tw/html/news/)




















40 絲路福音 TEXT / CW PHOTO / Andy、Tidus ART / Kw 多一倍的展品‧多一倍的驚喜 香港首個創世電視「中華聖經文物館」,在過去百日 預展期間,有一萬多人參觀,反應熱烈。新年即將來 臨,文物館於去年聖誕期間已展開第二階段,擴充至 三大展區,包括「中華聖誕文物展」、「聖經奇異生 物展」及「聖誕禮物研究所」。增加一倍的展品, 為參觀者帶來多一倍的驚喜,當中 更會首度展出100年前孫中山著 《倫敦蒙難記》及國寶級古地圖 《中華現勢地圖》原版,機會難 逢,展期有限,預約從速! 為參 更會 《倫 《中 逢 日 來 百年光影,從《倫敦蒙難記》到《生命因祢傳奇》 100年前孫中山著《倫敦蒙難記》 及國寶級古地圖《中華現勢地圖》原版登陸展館


















小金子專程來港親述喬宏父親喬義生 與孫中山的傳奇見證 唔講你唔知,國父孫中山與香港影帝喬宏淵源甚深,喬宏父親喬義生早年留學英國 學習醫學。求學期間曾傾身「孫中山倫敦蒙難」,求大義救孫中山,本立志做醫生的 他,後亦追隨孫中山的精神使命:救人必先救心,展開中國人的新一頁,並向兒 子喬宏教導基督信仰,傳福音的使命人生。
在『中華聖經文物館』《生命因祢傳奇》喬宏展區內展出,盼望在聖 誕及新年佳節,更多人認識主耶穌,就像我與喬宏一樣,生命因耶穌 基督而傳奇。」喬宏太太小金子於上月專程由西雅圖到港,特別為 「中華聖經文物館」帶來十堂精彩信息,場場爆滿,座無虛席!小 金子藉影帝喬宏的珍藏分享耶穌基督的福音,更親口述說喬宏父 親喬義生與孫中山救靈魂的使命。 來自大漢王朝的福音文告你見過未? 「漢代基督教福音銘文鏡」出土於徐州,銅鏡直徑為13.4厘 米,鐫刻工整清晰,中心區為四乳四神獸,四乳間各飾一獸,浮雕 造型精美。鏡邊為一圈18字銘文,被稱為基督教18字福音,短短18 字便充分涵蓋了基督教的核心信息。想知道是哪18個字?請即到「中 華聖經文物館」尋找答案! 基督教何時傳入中國一直眾說紛紜,只有在西安發現的「大秦景教流行 中國碑」記載了唐太宗貞觀九年(西元635年)基督教傳入中國的史實。有人 認為「漢代基督教福音銘文鏡」的製作年代為東漢後期,下限不應晚出曹魏,也就 是西元200到300年間,這一發現或使基督教傳入中國的文字記載提前400年。 親喬義生早年留學英國 山,本立志做醫生的 新一頁,並向兒 ,還可以 引》, 在聖 耶穌 為 小 父 厘 浮 雕 短 18 到「中 秦景教流行 國的史實。有人 不應晚出曹魏,也就 提前 400年。
「我十分掛念在香港的朋友,我非常感恩,雖然我已經92歲,還可以 來香港,我更會帶來喬宏的聖經文物,包括百多年前的《聖光日引》
















42 同場 展出 雙頭龜是百萬分之一的奇蹟 「中華聖經文物館」於聖誕及新年期間呈獻 「聖經奇異生物展」,多隻雙頭龜將同時現身,可 說是世界級的絕無僅有! 塑化雙頭龜絕密曝光 創世電視與大連生命奧秘博物館合作,全球搜羅 不幸夭折的雙頭龜遺體,交付大連生命奧秘博物館的塑化 專業團隊,將遺體組織定型塑化,保存雙頭龜原有型態在 「聖經奇異生物展」首度展出,參觀者有機會親手觸摸, 機會難得。 舉世聞名「耶穌蜥蜴」現身展館 在「聖經奇異生物展」的主要展廳,放置了一個巨大 的爬蟲展櫃,裏面是不同顏色的蜥蜴展示區,七彩繽紛, 定必是參觀者必到的打卡位。 古猶太教和猶太民族把蜥蜴看作不潔淨的動物,但有 一種蜥蜴卻擁有非常神聖的名字──耶穌蜥蜴,這稱呼的 起源是因為牠能在水面上行走! 牠們一般身輕如燕,不會打破水面張力的平衡,以合 適的角度擺動兩條腿,令身體向上挺、向前 衝,上演「輕功水上飄」!加上細長的腳 趾和腳底的鱗片,有利產生氣泡,使其 可以腳踏氣泡在水面上奔跑。 呈獻 ,可 光 全球搜羅 博物館的塑化 龜 原有型態在 會 親手觸摸,












步驟 1 步驟 2 步驟 4 步驟 5 步驟 3 禱告:每天為自己禱告,願能更有愛心陪伴親友;為 親友禱告,願他們答允邀請。 禱告後掛上「祈禱小立方」,猶如盛載禱告的馨香盒 子,成為漂亮又有意義的裝飾。 陪伴親友參觀創世電視「中華聖經文物館」,與他們 透過全新三大主題的展館「中華聖誕文物展」、「聖 經奇異生物展」及「聖誕禮物研究所」認識耶穌基督。 由聖誕禮物到新年祝福 以勒基金100棵禱願樹祝福全港 「中華聖經文物館」在聖誕期間,與以勒基金推 動「聖誕樹小立方祝福大行動」,鼓勵在佳節期間「知 恩、感恩、報恩」的精神。來到喜氣洋洋的新 年,以勒基金將繼續祝福大行動,讓你的祈禱與 祝願化成「祈禱小立方」掛飾,而每粒小立方 代表五小時的禱告力量,為社會各方帶來祝福。 在這片禱願樹森林裏,每一棵樹皆代表對中國對 香港的不同祝福,其中一棵名為「克勝危難」的祝福 樹,是特別為在紅館大型表演中,因巨屏塌下而受傷 的舞蹈表演者李啟言(阿Mo)的治療及康復祈禱, 而阿Mo父親李盛林牧師亦在本刊2022年12月號作聖 誕特別分享,以「克勝危難的倚靠」為題,藉基督降 生的信息及自己一家的經歷,鼓勵城中痛苦的心靈。 我們愛,因為上帝先愛我們,施比受更為有福! 100棵獨一無二的禱願樹,配合以勒基金提供的「祈禱 小立方」掛飾,同作義賣用途!鼓勵你陪伴親友參觀 「中華聖經文物館」,並憑信心認獻禱願樹,我們將奉 上「祈禱小立方」掛飾,成為你家中最別具心思的新 年喜慶裝飾! 活用禱願樹 分享屬天祝福 文物館特設「我講一句,你講一 句」祝福決志祈禱,需要你鼓勵親 友一同參與。 向親友分享福音,並鼓勵他們決志 後,填妥回應表,以便跟進聯繫。























44 扭蛋樂滿 FUN,扭出新年祝福! 在創世電視的全新展館──「聖誕禮物研究所」內,你會看 到一部巨型扭蛋機,裏面放滿色彩繽紛的扭蛋,等着你來抽!這部 扭蛋機不但外型龐大,裏面的扭蛋同樣別出心裁!每一顆扭蛋都是 獨一無二,盛載着一份特別的新年祝願,而每一份祝願都代表創世 電視20年來的各種祝福。 當你打開手上的扭蛋時,也是打開了創世電視的歷史大門, 並成為其中一分子,我們盼望這份意義非凡的禮物能夠成為你新一 年的祝福,更成為別人的祝福。邀請你來創世電視開放日,將一份 屬天的祝福、一段獨特的歷史帶回家,與家人朋友分享每顆扭蛋所 包含的美好信息,成就蒙福的人生! 立即報名 查詢熱線 3108 6031 (必需預約,每場人數有限)















































雲彩見證 TEXT / 皓恩 PHOTO / Andy & 受訪者提供 ART / JL 相信學音樂的人對柏茵音樂院( Parkland Music Institute )並不陌生,音樂院成立至今22年,成 功培育多名優秀音樂人才,甚至在疫情衝擊下逆行 增長,迄今建立了近60間分校,遍布全港各區。 生意蓬勃的背後並非靠自己聰明,關鍵在於凡事交 托,因着遇見上帝,老闆 Eddy 的經營觀念全然反 轉,使上帝所賜的祝福、所定的旨意能一一成就。 雲 46 Eddy 從「屋邨仔」到創立音樂學院: 柏茵音樂院創辦人 上帝才是真正的老闆 Eddy年輕時愛好結他。















經過柏茵音樂院時若你細心留意,便會發現每間 分校總不乏形形色色的導師和學生進出,門縫還偶 爾傳出彈奏樂器的聲音。長達三年的疫情無損音 樂院發展,反而助長生意,逆市開辦了十多間 分校。公司的發展看似一帆風順,但創辦人 Eddy 說當中經歷過許多波折,最終靠上 帝的帶領才得以逆水行舟。 由靠自己到靠上帝 柏茵音樂院於 2001年 成立,用一把結他走天 涯的Eddy 分享創辦 學院的初衷是以賺 錢為首。「我年輕時 做過不同工作, 後來在朋友啟 Eddy 當時獨自背起 公司各方面的壓力,後來太太 Venus 加入公司任總經理,情況一度 改善,因為她的親和力較強,正好補足了 Eddy 以理性作主導的性情。2010 年二人一起 上教會,但Eddy 自言感覺如同精神分裂,在教 會熱心愛主,回到公司卻是另一副臉孔。 發下投身結他導師行列,想以自己的技能賺取 更多金錢。」Eddy 是一名貼地的香港人,結 他對他而言是一件謀生工具,他在高峰時期每 月教近百名學生,每天由早上10時工作至凌 晨3、4時。「我自小在屋邨長大,家中不但貧 困,甚至欠下債務。為了分擔家人的債務,我 看錢越來越重要,也希望短時間內賺到足夠金 錢,於是累積了一些教資後便成立音樂院。」 當時公司由幾位員工發展至幾百名員 工,而同一時間 Eddy所背負的壓力驅使他不 斷用自己的方法逼同事成為工作狂人。「我是 一個不服輸的人,因此無形中為自己帶來很大 壓力。」他試過鼓勵同事不要放假、午飯時 間要半小時內完成。「公司的氣氛越來越 差,甚至有同事患上抑鬱,也有同事 因工作壓力每晚狂哭。」












































還有一次,公司同事偷錢,而且對方不是初犯。 「當時大部分同事都認為要報警,但當我想到報警 後,對方會留有案底,這會影響他一 生。」Eddy形 容那一次他腦海中浮現耶穌饒恕的教導(《馬太福 音》18章21-35節)。「主已經寬恕了我們的罪過, 我們也應該學習饒恕他人,於是我決定放過那位同 事,不再追究。」 按照《聖經》的教導行事,生意是否就會順風 順水、如日中天?訪談期 間,Eddy和Venus多番提 及感恩,直言公司發展並非一帆風順,每道難關皆靠 上帝度過。上帝不曾應許天色常藍,但祂應許在逆境 中會成為我們的幫助。 「猶記得數年前突如其來的離職潮,讓我們經歷 了信心的確據。」當時公司已擴展至十多間分校, 但在短時間內,一半同事因不同理由前後辭職,而 Eddy和Venus 正身處外地旅遊。面對人手大幅減 少,即使他們在海邊餐廳吃飯也食不知味,正當二人 48 Eddy、Venus與同事關係深厚。 次年,一次的崇拜講道把他們「點醒」。「當 時我聽到夏甲的事蹟,便知道上帝透過他們的經歷告 訴我,祂會祝福公司,如同祝福夏甲一樣。」據《聖 經》記載,夏甲和其兒子曾被迫離開家庭,流落曠 野,但夏甲在絕望中蒙主應許,她兒子必被拯救,其 後裔更必定會成為大國。 清晰的啟示讓 Eddy 的眼光不再一樣,他視柏茵 音樂院為對上帝的獻祭,停止過分管理同事,並以 《聖經》的真理思考如何透過教音樂,在他人的生命 播下福音種子。「在職場工作和在教會事奉的靈命不 應出現巨大落差,我曾經犯錯,但上帝也寬恕我,因 此在同事有困難時,我應該支持和幫助。」每當想到 天父的饒恕,Eddy便更懂得以上帝的愛與同事相處, 關係日益進步。 鍛煉信心:唯靠主的話語和經歷 當Eddy和Venus嘗試把 基督教的價值觀帶入公 司時,經營上卻遇到不同困難。「遵循《聖經》的 教導是最好的,可是有時卻難以拿捏寬嚴的尺度。譬 如說不論任何情況,是否必需按合約履行?特殊情 況下可寬容處理嗎?」Venus 坦言糾結的心態不易處 理,只能求上帝賜下智慧。






困境中看到天空十架雲。 憂心忡忡之際,竟然看到天空出現一塊十架雲。「那 晚海面風浪較大,讓我們不約而同想起耶穌平靜風浪 的事蹟,便深信上帝會與我們同行。」Venus說。事 實證明主的手從沒離開,經過禱告交托,回港後公司 很快請到足夠人手,問題迎刃而解。 疫情困局下 員工願共同進退 三年前疫情的來勢洶洶使許多行業停滯,甚至 損失慘重,但 Eddy 說音樂院不曾停下腳步,在經濟 蕭條下再辦十多間分校,背後全是上帝的恩典。「第 一波疫情來襲,感覺真如重演沙士災難,我們擔心這 次要關閉多少間分店,甚至結束公司。」在理性分析 下,Eddy 選擇花一筆資金作投資,以對沖損失,結 果他再次體會到上帝的方法總比人的方法好。 「一開始音樂院的生意確是比較淡薄,但感謝 主,政府沒強制要求琴行關閉,加上通關遙遙無期, 反而多了人來學音樂。」如果大家還記得,去年2月 第五波來得既急且猛,每天確診人數創新高,人心惶 惶之餘,所有活動全面停止,不少「打工仔」無故 被解僱。「當時不知道情況還要維持多久,難道真的 只能裁員嗎?」Venus 坦言同事都是很好的伙伴,不 忍心走到這一步。 就在這時,幾位資深員工主動提議,願意減一半 薪金與公司共度時艱,Venus 直言當時感動得快要哭 了。「最後我們沒有按要求減半,只是打了八折,也 答應之後會加薪。」上帝的安排往往出人意料,員工 多年來感受到老闆對他們的好,因而甘願在艱難時刻 作犧牲回報老闆。 第五波漸見緩和,柏茵音樂院恢復運作,如今 Eddy回 望公司的營運,發現盈利有增無減,讓他很 驚訝,並笑稱當初自把自為的投資行為,到頭來竟是 一場虧損。「人心籌算自己的道路,唯耶和華指引他 的腳步。」(《箴言》16章9節 )疫情前,Eddy和 Venus 以信仰為中心,努力改善公司文化;疫情中, 他們不單學習信心的功課,更親歷堅守信仰所帶來的 果效。





柏茵音樂院旗下的導師和同事。 去年舉辦聖誕音樂舞蹈活動。 50 感激恩主的供應與及時的同在 Eddy和Venus 在過去的日子飽嘗主恩,如今二 人都盼望報答主恩,餘生積極傳福音。「音樂是上帝 所賜的美好禮物,我希望將這份禮物帶給更多人, 以往我們在其他機構義教時才有機會傳福音,但上帝 感動我們,使我們看見最大的禾場其實就在柏茵音樂 院。」Eddy 說公司人才濟濟,無疑是一片傳福 音佳地,而有些導師是基督徒,他 們會把在教會敬拜或詩班所學到 的,傳授給有興趣的學生,間 接播下福音的種子。 獲得財富卻失去性命,值得嗎? 柏茵音樂院的發展在主的庇護下漸入佳境, 正當二人同心經營生意,不料 Venus 的身體出現狀 況。「不知哪天開始,太太起床便感到天旋地轉, 看了醫生也不知道原因。」當時 Eddy 十分擔心,繼 而按醫生吩咐陪 Venus 照磁力共振。「檢查前護士 才說要注射一支顯影針,而每40萬人便有一人會因 顯影針沒命,我害怕太太進去後無法活着出來,焦急 間上帝對我說不要擔心。」Eddy 笑着看了 Venus一 眼,他強調沒有太太便沒有今天的他,無法承受失去 對方的痛苦。 Venus 形容躺在檢查儀器上,感覺像躺在棺材。 「我心裏很懼怕,不斷默默禱告。」神奇的是,禱告 中Venus 聽到上帝清晰地對她說:「乖女,不要害 怕。」因着上帝一句安慰的說話,Venus 安心地進行 檢查,慶幸得出的結果不是大病。 「人若賺得全世界,賠上自己的生命,有甚麼益 處呢?人還能拿甚麼換生命呢?」(《馬太福音》16 章26節)「以前我對金錢看得極重,也自私地掌控員 工,但現在我深深明白,人有許多事情都是身不由己 的,成為億萬富 翁也不代表擁有 一切,因為上帝 才是掌管萬有。」 面對生死關口, Eddy 自言感觸良 多,如今他褪去 舊我,不再盲目 追求財利,讓主 掌管一生。




教室門口貼有聖經金句。 Eddy、Venus常禱告親近主。 「早年我們成立了柏茵音樂基金會, 大部分同事都是基督徒,他們在公司小 型聚會中與同事分享信仰,讓未信者循 序漸進地了解基督教,部分同事在考慮 是否接受,更有同事在遇到困難時嘗試祈 禱。」Venus 認為輕鬆小聚讓同事更易接受 信仰,而活出耶穌基督的樣式比硬銷信仰更 加重要。 談及公司的未來發 展,Eddy 指尚在計 劃中。「但我們明確知道一件事──這盤 生意是屬於上帝的,祂怎樣安排,我們 就怎樣行。」如《箴言》16章3節 所說:「你所做的,要交托耶和 華,你所謀的,就必成立。」信 仰沒法與生活分 割,Eddy從成立公司以來歷 盡風雨,終在主裏明瞭這道理。 一日之計在於禱告仰 望,Eddy與Venus 習慣工作前先祈禱交托。「我們常常求主提 醒,自己的言行舉止是否合祂心意。」昔日 Eddy 是為錢拼搏的小伙子,如今他放下自己 的慾望,順服主的帶領。人生非諸事順利,總 會遇到許多艱難,但從 Eddy、Venus的經歷 中,我們明白到上帝是滿有恩典的供應者,時 刻與信靠祂的人同在。 倘若一天如 Eddy所盼,柏茵音樂院在主 的帶領下擴展至亞洲以外的地方,相信會有更 多人透過音樂得着盼望與安慰。 。





















感謝年屆九十二高齡的喬媽,因看重福音的價 值,上月願意從西雅圖專程來港,把喬宏叔家族與《聖 經》及歷史相關的文物徵集並進駐「中華聖經文物館」 之中,並在文物展會員場中親身分享。出席參與的會 員都深被感動和激勵,願意起來接續喬媽和喬宏叔傳 福音的棒!喬媽現雖返美,仍誠邀大家趁新春攜同親 友蒞臨參觀,傳承不一樣的生命傳奇! 新春會員場: 6/1 (五) 3:00pm 13/1 (五) 7:30pm 17/1 (二) 3:00pm (參觀時間約2.5小時) 網上報名 誠邀你掃瞄QR code報名參觀。任何疑問,歡迎致電會員部熱線:3108 6012
奉獻者資料:( 為方便電腦處理,請盡量以英文正楷填寫。) 姓名:(中) (英) 性別: 通訊地址: 聯絡電話: 電郵: 年齡: 17歲或以下 18至29 30至39 40至49 50至59 60或以上 職業: 所屬教會: 我已定期收到使團通訊: 否□ 是□ 收看創世電視的頻道: □ myTV SUPER 602台 □ 網站 □ 創世電視APP 以下宣教工具只適用於會員選取︰ 指定取《天使心》月刊的OK便利店店舖號碼: (詳情請瀏覽《天使心》月刊的「OK便利店取書地點」名單) 奉獻方法 信用卡(可直接傳真至2763 0570) VISA MasterCard 信用卡號碼: 持卡人姓名(英文正楷): 信用卡有效日期至: 月 / 年(最少兩個月內有效) 簽署日期: 簽署: 自動轉賬(授權書將稍後寄上)(只適用於每月定期奉獻) 劃線支票(抬頭請寫「The Media Evangelism Limited」或「影音使團有限公司」,連同此回應表一併寄回影音使團總辦事處, 信封面註明「《天使心》月刊回應表」) 現金存款 **/ 轉賬 (將款項存入恆生銀行賬戶號碼 235 -270717- 668 或匯豐銀行賬戶號碼 123-125155-001,並將存款收據及此回應表一併寄回影音使團總辦事處。封面註:「《天使心》月刊回應表」) ** 為避免銀行收取櫃員服務費,請盡量透過自動櫃員機捐款。 繳費靈PPS:致電「繳費靈」電話18013登記,登記完成後請致電18033,按指示輸入閣下之電話號碼或#會員編號, 輸入奉獻金額及記下付款編號。影音使團的繳費靈商戶號碼為「9445」 PPS付款編號: 閣下之電話號碼 / 會員編號: 奉獻日期: 金額總數: 每月繳款後,請將閣下之會員編號及上列資料郵寄或傳真到影音使團辦理(如已傳真資料,切勿郵寄以免重複。) 請注意: 上述個人資料將會用於影音使團發放訊息,包括會員及義工通訊、代禱家書、活動/課程推廣及邀請、籌募需要、開立收據、 招募義工及收集意見等。如有任何查詢,請致電2209 6280與影音使團聯絡。 不接受 影音使團為註冊慈善團體,捐獻HK$100或以上可憑收據於香港申請免稅。 需要奉獻收據 會員熱線:3108 6012 備註:#會員編號將於收到填妥之參加表格兩星期後發出。 收到填妥之表格一星期內,將有專人聯絡核實以上資料。 所有個人資料只供上述計劃及其相關活動使用。 條款及細則:1. 送出之宣教工具及精美禮品數量有限,先到先得,送完即止。 2. 以上優惠不適用於一年內曾經參與「會員計劃」的舊會員。 請於合適 內劃上 請填妥下列表格連同存款收據,寄回影音使團總辦事處或傳真至2763 0570 1. 我願意參加「會員計劃」 每月定期奉獻 支持影音使團事工,每月奉獻港幣: □HK$350 □HK$550 □HK$1,000 □HK$2,000 □HK$3,000 □或以上HK$______________ (如適用)推薦會員姓名: 電話: 2. 我願意奉獻支持《天使心》月刊印刷經費,奉獻港幣: □HK$1,000 □HK$2,000 □HK$5,000 □HK$10,000 □或以上HK$______________________ 3. 我願意奉獻支持「創世電視」平台營運、租賃及製作經費,奉獻港幣: □HK$1,000 □HK$2,000 □HK$5,000 □HK$10,000 □或以上HK$______________________ 活出一個傳福音的人生誠邀加入成為會員,同行媒體宣教路 AHM23-01 敬請按感動回應,並鼓勵更多人參與支持。 影音使團總辦事處:香港九龍觀塘鴻圖道一號2樓2-3室 查詢熱線:2209 6280 傳真:2763 0570 影音使團網址:www.media.org.hk ‧創世電視網址:www.creation-tv.com ‧天使心網址:www.media.org.hk/angelheart ‧電郵:info@media.org.hk 影音使團個人資料私隱政策請參閱:http://www.media.org.hk/tme_main/index.php/privacy_policy







天恩傳奇 TEXT / 恩勻 PHOTO / 飛 ART / Kw 當緬甸「古惑仔」 遇上天恩宣教中心 天 54 訪問寶昌是一個持久戰,我們常常訪問到 到一半,他就被其他小朋友喚去幫忙,煮 飯、教導功課、處理雜務⋯⋯ 在我眼中,除了手臂上顯眼的紋身外,寶 昌就跟其他17歲青少年無異,很多時間 說話都是客客氣氣的,還偶爾帶點靦腆。 後來才從寶昌的親妹妹口中得知,看似溫 文的寶昌,曾經是一位被家人放棄的緬甸 「古惑仔」! 到底這位從前家人眼中的小混混、大魔 王,是如何慢慢「變好、變乖」?這一 切都要由寶昌的背景說起。





戰爭讓父親沉淪毒海 寶昌父親是緬甸人,在年輕時染上毒癮,之後到 泰國戒毒因而認識福音,成功戒毒後決志修讀神學並 成為了傳道人。可是好景不常,據寶昌說,是戰爭讓 他父親再次染上毒癮。 在這樣的家庭背景下,寶昌生出叛逆之心,常常 跟家人作對。我們讓寶昌形容一下自己是怎樣的「古 惑仔」,他帶點害羞地說,以前常常跟朋友在街上流 連不回家,如果覺得有誰在瞪自己,就會聯合朋友一 起「教訓」對方。 寶昌又說到毒品在自己家鄉很普遍,偶爾經過比 較偏僻的小巷街道,便有可能撞破別人吸毒。因為這 個原因,加上緬甸爆發內戰,寶昌母親便急忙聯繫萍 秀傳道,希望把寶昌送到天恩宣教中心(下稱「天 恩」)。縱然不捨,但母親更希望寶昌能遠離戰爭、 毒品和暴力,在一個充滿愛和福音的生活地方長大。 初來乍到嚇壞傳道人 我們特意訪問了「天恩」的負責人萍秀傳道, 讓她說說跟寶昌初次見面的情景,原以為是一個感人 的開場,沒想到萍秀傳道臉色微變,說道:「現在想 起來還是心有餘悸!」 她解釋說自小在基督教家庭長大,從小到大都很 尊重母親,而寶昌來到「天恩」的第一天,即便即 將與親人分離,他沒有表現得依依不捨,更對母親呼 呼喝喝,甚至以粗口相對。萍秀沒想到「天恩」會 來了一個這麼有氣場的小霸王,笑說:「為甚麼當初 寶昌的父母沒有說到會這麼難搞啊。」 「天恩」本着愛的宗旨,接收所有合資格的緬甸 難民兒童。縱然寶昌是一個讓人難以接近的小混混, 反而讓萍秀更想對他傳福音,因為她深信人唯有依靠 基督,才能得着真正的生命。 長在基督教、討厭基督教 問到寶昌當初來到「天恩」的感受,他說雖然 從小在基督教家庭長大,父親更曾經是傳道人,自己 卻從未真正了解過基督信仰。 在寄宿「天恩」之前,寶昌對於基督信仰沒有好 感。對他而言,基督教家庭背景甚至是個限制,讓他在 一群佛教親戚中顯得格格不入。他只知道自己不能跟其 他親戚孩子一起燒香、不能祭祀祖先、不能吃祭品, 卻不明白為甚麼不能做,因而漸漸討厭起基督信仰。 重生 所有在「天恩」生活的孩子都不可避免要學習 基督信仰,寶昌堅硬的內心慢慢被耶穌基督的愛感動 和軟化。決志信主後,寶昌的屬靈亦得以成長,漸漸 改善了壞脾氣,做事變得有耐性,更開始會主動關心 家人。從前的他甚少聯繫母親,每次通話都是以吵架 收尾。但信主後,寶昌開始意識到過往對母親態度是 不對的,因而主動跟母親道歉,並會在通話中主動關 心對方。









56 「她那時候嚇到了!」寶昌笑說母親一開始並不相信自己真 的變好了,直到後來的通話聯繫變多,母親才感覺到兒子真的跟 以往不一樣了,就像是「重生」。 問到「重生」的契機,寶昌回答大概是被基督的愛感動。寶 昌接觸福音以後發現,耶穌真的很好,肯為世人犧牲自己。尊敬 耶穌的同時,寶昌也漸漸地向耶穌靠近,他開始反省自己的錯誤 並嘗試效法耶穌的行為。 寶昌那顆燥熱的心就這樣慢慢平靜下來,變得包容和比較平 易近人。除了協助煮飯,寶昌更負責教其他孩子中文和督促年紀 較小的孩子的行為,儼如一位可靠的哥哥。 一人信主,一家必得救 《使徒行傳》 16章31節寫到:「當信主耶穌,你和你一家 都必得救。」我認為寶昌的經歷完美地見證了這句話。 早前提及,寶昌的親戚都是非基督教信仰的,更多的是佛 教。但在這樣的背景前提下,我居然在「天恩」遇見寶昌的親戚 們。接近20位小朋友,全都來自寶昌的家族,當中包括寶昌的親 妹妹、叔叔的子女、嬸嬸的兒子等。 歸根究底,親戚們都被寶昌的見證感動了。縱然他們還不認 識基督教,仍願意接觸基督,尋求基督保護自己的孩子,在遠離 罪惡的環境中長大,並且像寶昌一樣地變乖。因此,所有親戚都 紛紛將家中孩子送到「天恩」接受教育,希望孩子們「聽耶穌」。











晨禱、飯前祈禱、聖經課、敬拜、晚上崇拜、周 日崇拜等,讓無數孩子在「天恩」裏有了接觸福音 的機會。寶昌笑說親戚的孩子們雖然還沒有信主,但 已經對信仰產生了興趣,更會與自己討論福音。 我們祈禱希望「天恩」能讓更多的孩子,像寶 昌一樣在福音當中重生,認識到生命的意義! 我從不放棄任何一位孩子 在寶昌的感人見證當中,萍秀傳道絕對是一位不 可或缺的角色。究竟萍秀傳道十年來的「當媽媽」 心情,有沒有曾經一刻想過放棄?她坦言十年當中確 實面對過各種挑戰,包括資金不足和孩子不聽話,但 不論面對任何難關,她從不放棄任何一位孩子,因為 她相信上帝是愛。 萍秀傳道分享曾有一位叛逆的孩子在上課期間失 蹤,疑似離家出走。萍秀知道後第一反應不是生氣, 而是滿滿的擔憂,她擔心這一個無國籍的少年在泰國 難以生存。她和「天恩」的其他孩子徹夜尋找,卻不 見那青年的影蹤,毫無辦法的她只能求助上帝,她不 斷在心裏默念:「上帝啊,求你不要不顧這個孩子, 不要讓他孤單一人,如果他能平安回來,我會以加倍 的愛感動他。」 幾天後,那青年居然帶着滿身傷痕回到「天 恩」。查問過後,發現青年當時在午休期間,受一把 聲音召喚進入了森林,然後受傷昏迷了一天一夜。醒 來後,他才發現自己滿身傷痕,心裏只想着逃離森林 回到「天恩」。 這位照顧過數百位孩子的堅強「母親」,時隔 數年回憶起那次意外,還是激動得哭了。看着萍秀傳 道伸手在墨鏡後默默拭淚,我知道,她是真的把「天 恩」的孩子當成自己的親生孩子一樣心疼。 十年酸甜,唯有上帝帶領! 今年是「天恩」創立十周年,當中「有酸有甜」, 萍秀傳道卻說從未萌生放棄的念頭。至於遇到難以解決 的問題時如何處理,她直言就只有祈禱。 「人太脆弱,連自己長痘痘、脫髮這種小事情都控 制不了,如何控制自己人生?唯有上帝帶領!」 「天恩」致力收留金三角無國籍難民兒童,為他們 創造安穩的生活環境,以愛照顧並確保所有孩子可以上 學,將來得以自立。 金三角仍有不少孩童生活在水深火熱之中,得到 的支持越多,「天恩」就能拯救更多孩子。如果你認 同「天恩」的宗旨,我們希望在此呼籲你認養「天恩」 的孩子,你每月的奉獻都會用在孩子身上,幫助他們 平安成長。
























請將表格WhatsApp致 6537 5152 或電郵致 hkgcl@media.org.hk,我們將有專員與閣下聯絡。 另,邀請大家按聖靈感動並回應,歡迎直接捐款到以下戶口: 影音使團於恒生銀行專款專用戶口 369-431457-001 註:影音使團為註冊慈善團體,捐款HK$100或以上可憑奉獻收據於香港申請免稅。 姓名: 電話/電郵: 助養兒童姓名/一次過奉獻: 助養泰北天恩難民兒童 WhatsApp 我不願讓你獨行,我要與你一起成長! 加入泰北天恩難童助養行列 泰北天恩救助來自緬甸的難民兒童,祈盼得到您的參與,以愛還愛,共證天恩。 只需每月港幣800圓,便可助養一名天恩難民兒童,讓他們在衣、食、住及學費上有 充足資源,健康成長,在天恩大家庭中經歷主愛。 子俊 16歲 皓月 9歲 志芳 15歲 佳恩 7歲 恩惠 5歲 力忠 6歲 子孀 16歲 開心 10歲 李湘13歲 凱華 16歲 吳杰 16歲 佳霖 12歲 恩友 10歲 樂音 15歲 吳恆 13歲






















長久以來,教會傳福音的方式大多是集中式的, 也就是自己開佈道會。但是佈道會比較像是教會 事工,門徒所能夠做的「最偉大」的事,就是把 新朋友帶到佈道會現場,最多是負擔計程車的車 費,就很了不起了。門徒從中並沒有真正做到傳 福音的使命,而且在這過程中並沒有很多學習和 神蹟同行 《馬可福音》16章20節 :「門徒出去,到處宣 傳福音。主和他們同工,用神蹟隨着,證實所傳的 道。阿們!」門徒出去宣傳十字架的福音,世 人一定會問:「我怎麼相信你的話 呢?我怎麼知道你講的是真的還是 假的?」耶穌要我們傳福音,一 定有想過這個問題,不然就不是 負責任的上帝。 幸福學堂 TEXT / 天使心編輯室 PHOTO / 互聯網 ART / JL 楊錫儒牧師 福氣教會主任牧師 幸


耶穌必需證明你今天所傳的福音是出於上帝,給 你蓋章,可是祂沒有給我們委託書,所以這段經文告 訴我們,祂要用神蹟奇事來證明我們所傳的福音。 神蹟奇事與愛 神蹟不是讓我們來過癮的,不是要來增添我們 的面子的,不是來增加我們的威風的,是為了證實我 們所傳的福音。神蹟奇事就是異乎常理的事,變水為 酒是神蹟,瞎眼可以看見是神蹟,瘸腿可以走路是神 蹟,五餅二魚餵飽一萬人是神蹟,死了的拉撒路可以 復活是神蹟,所以在甚麼情況下耶穌會用神蹟奇事來 印證我們所傳的福音呢? 門徒出去,然後到處宣傳福音。你有沒有從經 文裏感受到門徒一種很積極的態度?重點不是「到 處」,重點是一種持續性,你可以從這句話中體會到 門徒傳福音是很積極、很主動,而且是持續不斷的。 過去佈道會在教會開辦,我們必需把 best帶到教會 來,而不是門徒出去。門徒出去代表我們去找羊,不 是羊找我們,這是很積極主動的態度。當門徒如此重 視傳福音工作時,上帝就用神蹟奇事來印證我們所傳 的福音。 《哥林多前書》13章1-3節 :「 我若能說萬人 的方言,並天使的話語,卻沒有愛,我就成了鳴的 鑼、響的鈸一般。我若有先知講道之能,也明白各 樣的奧秘,各樣的知識,而且有全備的信,叫我能夠 移山,卻沒有愛,我就算不得甚麼。我若將所有的賙 濟窮人,又捨己身叫人焚燒,卻沒有愛,仍然與我無 益。」這段經文中保羅共說了三個「我若」,他用 假設代表一個人一般做不到的事,你不會沒事就捨己 身叫人來焚燒,即便你可以做到這個程度,已經很不 得了,但沒有愛的話,就是鳴的鑼、響的鈸。鑼和鈸 能夠發生很大、很尖銳的聲音,但是後面甚麼事都沒 有,意思是,就算你做了這些事,但因為沒有愛的緣 故,所以不可能有後續的影響力。保羅的意思就是 說,愛是神蹟奇事的基礎,但是愛的位階比神蹟奇事 更高,因為如果有轟轟烈烈的神蹟奇事,但沒有愛作 為核心價值的話,那只不過是一時的鞭炮放過來讓你 嚇一跳而已。保羅並不是因為不會行神蹟所以批評那 些行神蹟的沒甚麼了不起,反而他行過很多神蹟,最 能理解神蹟奇事和愛之間的關係。 兩種彼此相愛 《約翰福音》13章 34-35節:「我賜給你們一 條新命令,乃是叫你們彼此相愛;我怎樣愛你們,你 們也要怎樣相愛。你們若有彼此相愛的心,眾人因此 就認出你們是我的門徒了。」舊約告訴我們要愛鄰舍 如同自己,為甚麼耶穌說這是一個新命令?祂主要的 目的在告訴我們,這個新命令彼此相愛的方式不是你 們原來的方式,而是要有一種新的愛。 門徒彼此相識,如同我們在教會彼此相識,我們 會不會有感情呢?會啊。有感情就會彼此相愛了。可 是我們的彼此相愛有一個前提,就是我們不單是人, 還是罪人,罪人的愛不會是無私的愛。我們彼此相 愛,是因為你對我好,那我當然要對你好。這種愛是
時也彼此相害,他們會不會從我們的身上認出我們是 主的門徒?他們會說你們和我們是同樣的貨色,因為 你們愛的方式和我們是一樣的。為甚麼教會的福音會 傳不出去?因為我們的愛和社會的愛是一樣的,所以












62 神蹟同行
有條件的愛、自私的愛。當你對我不好時,我們就要 彼此相害。所以我們這種愛是靠不住的愛、隨時會調 整的愛。耶穌說這個愛是沒有用的,現在頒布給你們 一個新的命令,就是我怎樣愛你們,你們就用這種愛 來彼此相愛。而且如果你們這樣相愛,眾人因此就認 出你們是祂的門徒了。眾人就是教會以外的社會上的 人,他們會不會彼此相愛?會啊。翻臉的時候會不會 彼此相害?會啊。如果我們在教會裏彼此相愛,翻臉
眾人因此認出我們不是主的門徒。可以認出是甚麼意 思?代表我們這種愛和他們的愛是不同的,這是一個 標記。 《哥林多前書》13章4-8節上:「愛是恆久忍耐, 又有恩慈;愛是不嫉妒;愛是不自誇,不張狂,不作 害羞的事,不求自己的益處,不輕易發怒,不計算人 的惡,不喜歡不義,只喜歡真理;凡事包容,凡事相 信,凡事盼望,凡事忍耐。愛是永不止息。」愛不是 你們說了算,不是你們去定義,保羅有一個天上的標 準,耶穌的愛是犧牲的愛,我對耶穌很好嗎?有給祂 恩重如山所以祂要為我犧牲性命嗎?我們不但沒有對 祂很好,還是祂的仇敵,所以《聖經》告訴我們, 我們在做祂仇敵的時候,祂為我們上十字架。為好人 死,可能有;為義人死,可能有;可是為仇敵死,從 來沒有聽過這件事,《聖經》說上帝的愛就是這樣顯 明的。不該死的為我們死,好叫我們這些該死的不必 死,這就是十字架的原型。現在耶穌告訴我們,你們 領受了這樣的愛,就要用這樣的愛來彼此相愛。 經得起看的門徒
令就是要讓你們學習一種新的愛,而這個新的愛是違 反人性的。 《彼得後書》1章7節:「 有了虔敬,又要加上 愛弟兄的心;有了愛弟兄的心,又要上加上愛眾人的 心。」為甚麼愛弟兄還不算,還要愛眾人?因為愛弟 兄有脈絡可循,如果只是愛弟兄、愛朋友、愛認識的 人、愛跟你有關係的人,這個愛基本上還是在自私的 愛的範疇。如果大家都是這種自私的愛,福音怎麼可 能傳給萬民、傳到地極呢?所以福音要能夠往外傳, 必需翻盤,門徒是福音的見證者,就要經得起看,就 是你跟世人不同,必需被認出是主的門徒,我們才會 有公信力。
保羅所講的愛大概都是我們做不到的事,一定會 做相反的事,愛是恆久忍耐,我們就是沒辦法忍耐; 愛是不求自己的益處,我就一定會自私。你不忍耐, 一天到晚都在自私,會發生甚麼事?你會跟別人衝 突、跟別人紛爭。原來耶穌給我們下一個新命令,是 為我們能夠好好活,因為耶穌說我來了要叫你們有豐 盛的生命。祂透過保羅告訴我們愛是甚麼,這個新命





















國度角度 TEXT / 何寶生 PHOTO / 互聯網 ART / JL 國 64 中央化與 去中央化之爭論 何寶生傳道 「權力使人腐化,絕對的權力使人絕對的腐 化。」(Power tends to corrupt, and absolute power corrupts absolutely. )這名言乃出自阿 克頓1887 年的著作《自由與權力》。歷史已 經一再證明其真確性,所以也被奉為無容置疑 的金科玉律。為了制衡絕對的權力 ( 獨裁者) 所帶來絕對腐化之惡果,因而產生了三權分立 (立法、司法、行政)相互制衡的民主政體。這 在世人而言,當然有其正當性與合理性,但若 從《聖經》的亮光及所啟示的天國觀來看,我 們當信奉的是屬世的金科玉律,還是屬天的真 理?為免我們不至因誤判而與天國的法則背道 而馳,越行越遠,對《聖經》一貫啟示的深度 認識尤為重要!
















(本文引用自《國度復興報》) 根據《詩篇》2篇及《啟示錄》17章12-14節 給天國子民有關末世的預言及啟示:世上的萬民、 君王、臣宰,將聯合起來一同敵擋耶和華和祂的受膏 者基督耶穌 (《詩篇》2篇1-2節),而世上的君王 將同心合意將他們的權柄高度集中起來,給予那獸 (Super Power) ,好與羔羊(受膏君基督)決一 死戰,至終羔羊必勝過他們,因為羔羊才是真正的萬 主之主、萬王之王,同着羔羊的,就是蒙召、被選、 有忠心的,也必得勝 。(《啟示錄》17章12-14節) 主竟願將自己完整的身體擘開(捨了),分賜給我們 (《哥林多前書》11章24節),至終為要贖回一個父 與子及新婦,完全對齊合一的家、身體與教會。主餐 只是一個儀式,還是表明一個盟約、信念與行動?教 會去中央化,會否正與此心願背道而馳?值得牧者信 徒深思! 當法利賽人指控抹黑耶穌是靠鬼王趕鬼的時候, 耶穌直斥其非及邏輯謬誤。(《馬太福音》12章 24-30節)可見天父的兒女、天國的子民若要戰勝魔 鬼黑暗國度,就必需效法基督犧牲小我、完成大我的 「捨己」精神,至使主的身體、教會及新婦都與耶和 華軍隊的元帥、天國受膏君基督耶穌完完全全地高度 對齊合一,因為主說,不與我相合的,就是敵我的。 《啟示錄》更清楚告訴我們:當七號吹響之時:世上 的國成了我主和主基督的國,祂要作王,直到永永遠 遠 。(《啟示錄》11章15節)保羅曾經與主背道而 馳,大大逼迫及分裂教會,但當他被聖靈更新以後, 卻語重心長地囑咐教會,要竭力保守聖靈所賜合而為 一的心,且應許說,在日期滿足的時候,使天上、地 上、 一切所有的都在基督裏面同歸於一。 近日有一種新思維正方興未艾——由中央化到去 中央化(From Centralize to Decentralize),並且 討論之風已經吹向教會群體,尤其是在疫情期間,教 會聚會由實體轉向虛擬,更加劇了這種張力。究竟對 齊與對立、集中與分散,孰優孰劣?教會當如何小心 謹慎地選擇一條合乎《聖經》,又適切現實環境需要 的更新路向,以致不因誤判而全軍覆沒?正確的認知 與選擇,此刻顯得更為重要!






66 畫中畫| TEXT & ILLUSTRATION / Garyee 畫 毛毛聊CinGaryee 是一人插畫品 牌,Garyee(嘉儀) 就是畫師的名字。主要用毛筆為創作媒體,多以聖經和 動物作主題,以新舊交融的方式創作一幅幅正能量作品。 https://www.facebook.com/momogaryee

























68 葉家寶 創世電視榮譽顧問、 前亞洲電視執行董事。 人生總是充滿驚濤駭浪,但上帝總在保 守看顧,只想盡心盡意侍奉祂。 葉家 創世電 創世世電視 前亞洲電 人生總 人生 人 是 守看顧 看顧 看 守看 守 顧 家有一寶| TEXT & PHOTO / 葉家寶 ART / JL 2023年伊始,首先恭祝各位新年進步,主恩豐 盛,「舊事已過,都變成新的了」!今年是我踏入媒 體行業的45周年,期望可以好好記載這45年的媒體 歲月,希望每年都找到一些特別的人和事,藉每年的 一幀相片,勾起對人生的領悟。所以不能怠慢,從今 天起,就努力向標杆直跑。 去年接受了國際天恩基金 會創辦人李世勳牧師及影音使 團總幹事袁文輝先生的邀請, 加入了餐飲行列。因為位於鴻 圖道 1號地下的「天恩1號食 堂」,於去年2月14日情人 節、疫情最嚴重的時候開業。李牧師以「人以食為 天,民以食為膳」為食堂營運宗旨,用以「食」為 「善」的「饍」字做金漆招牌,一開業已關心周遭 有需要的朋友,透過不同的基督教、天主教機構,向 低收入家庭、露宿者派飯,在善長的支持下,每個月 都派出超過一千個飯盒,給有需要的朋友提供適時的 溫飽。 冬至是中國人十分重視的節日,所謂「冬大過 年」,所以去年冬至日,食堂向居住在觀塘區的低收 入獨居長者、劏房戶家庭派飯,並派送聖誕禮包,包 括頸巾、手套、茶葉等,向他們送暖,送上上 帝的祝福。寄望 2023 年每月都能派出二千個飯 盒,希望祝福更多需要溫飽的朋友。 過去食堂都開放予附近的劏房家庭,在下午 時段可用食堂的空間溫習或學習手工藝,在節日 可一家大小一同包糭或製作月餅等。稍後食堂將開辦 課程培育飲食接班人,亦會聘用一些更生人士、弱勢 社群,讓他們與社區共融,期待更多的善長仁翁可以 捐獻贊助支持我們這些慈惠活動。 冬至日派飯邀請到不少演藝人士參與,包括愛 心爆棚的第一屆亞姐冠軍黎燕珊, 以及黎淑賢(1995亞軍)、黎虹讌 (1991亞軍 )等亞姐,還有魏秋樺 及劉錫賢,以及遠道從西雅圖回港 的小金子(喬宏太太)。一眾表示 做善事是最開心的「任務」,因為 施比受更為有福。當天得到觀塘區 議會一眾嘉賓支持,包括呂東孩副主席、林瑋議員、 許有為議員、龐智笙議員及金堅前議員等出席,立法 會議員顏汶羽博士亦專程到來打氣,好不熱鬧。 在餐飲行業來說,我可算是一名初哥,仍有許多 值得學習的地方,希望可透過與不同食客的溝通,不 單知道他們對我們的飲品食物的評價,還可了解到他 們心靈的渴求,從而將自己已得到上帝上好的福氣, 與他們分享。 求賜我信心、勇氣和希望,使我成為生命的 鬥士! 從媒體 到 餐飲 新年進步,主恩豐 可 68









吳桂行傳道 影音使團福音事工總監 70 行哥行傳| TEXT/吳桂行傳道 ART/JL (一) 硬漢子聽了道幾十年,無數人向他傳福音,他都 不肯信主。 我不認識他,有一天他患了癌症,他的學生關心 他,邀請我家訪他,向他傳福音。 他患了癌症,幾痛也堅持做運動,痛到扒在地上 也要移動手腳去做運動,真硬漢子也。 我內心提醒我:「他聽了幾十年道,不用再和他 講道理,只分享得救見證就可以了!」 家訪日我分享得救見證,之後邀請他信主,他一 口拒絕。 我從不勉強他人信主,留了一會便離開。 離開其門口,在等升降機前,他追出來說:「行 哥,我都係今日決志信主!」 Amazing! 我們立即返回其家,他一句一句跟我開口決志祈 禱相信接受主耶穌基督為救主。 Glory be to our Father! 我看見他信了,未信主的太太在旁,沒理由不向 她傳福音,於是又引導她信主,她又一句一句跟我開 口決志祈禱相信接受主耶穌基督為救主。 Glory be to our Father! 不久,他安返天家。 太太自己去崇拜。 (二) 姊妹邀請我家訪一位好朋友,她住得很遠。 感恩,為了傳福音,幾遠都去! 上主給了她機會從迷信黑洞中逃出來。 All is God's grace! 之後,她的弟弟患了癌症,姊妹和我家訪他。 眼前黑黑實實、健健康康、精精神神的一名運 動教練,不敢想像他已被醫生判了死刑、沒得醫的 末期癌症病人。 我分享福音和個人見證。 我記得此乃第一次在個人談道分享中提及我曾 入讀的第二間小學——上水石湖墟田料米業商會公 立學校(第一間小學是大澳永助學校)。 他立即高興地叫了出來:「噢!米田共,大師 兄,你都喺米田共讀書。」 大家是米田共校友,「好好傾」。 感謝主!他十分願意一句一句跟我祈禱決志相 信主耶穌基督為救主。 隔了一段短時間,他安返天家了! 天上又多了一位我親自引領信主的老友記。 日後天上見! Glory be to our Father! Many many thanks for all your prayers and support as always! God bless you! 願榮耀歸天父! 70










主恩 常在 敬畏耶和華是智慧的開端,認識至聖者便是聰明。箴9:10


生活文化 ‧男心女意| TEXT / 何志滌、羅乃萱 ART / JL 生 72 何志滌牧師 畢業於加拿大麥基爾大學(McGill University),後在 安省神學研究院( Ontario Theological Seminary)獲 道學碩士學位。他與妻子羅乃萱蒙召往台灣宣教,四 年後回港服侍教會,曾任播道神學院和中華神學院特 約講師。現任中國基督教播道會同福堂創堂牧師。 記得十多年前,教會舉辦了三場「愛筵」,目 的是招呼一些生活上有需要的街坊。「愛筵」當天, 第二場與第三場相隔三個小時,看到很多年輕同工很 疲累,就告訴他們,不如大家休息一個小時吧。無論 任何年紀,若付出過多的體力一定會累。先知以賽亞 不是說:「就是少年人也要疲乏困倦,強壯的也必全
一)為何要等候耶和華?:對有信仰的人來說, 耶和華是上帝,《聖經》描述這一位上帝「不打盹、 不疲乏,也不困倦」。更重要是「疲乏的,祂賜能 力;軟弱的,祂加力量」,可以說祂是一位關心和看 顧我們的上帝。所以,當我們疲乏時,祂絕對不會不 理會我們,一定賜給我們能力,是值得我們等候的。 二)到底「等候」甚麼?:雖然以賽亞沒有告 訴我們等候甚麼,卻給了我們結果,就是會「如鷹展 翅上騰,他們奔跑卻不困倦、行走卻不疲乏」。我跟 師母最常被問及的問題是:「你們為何那麼忙碌,難 平靜 作息有時 道不累嗎?」我們的回應是:「作息有時。」其實, 等候就是停下來,讓我們不要埋在忙碌裏。 有三個「作息有時」的建議: 一)睡個午覺:在台灣事奉四年,發現那邊的 生活習慣就是午餐後都會睡午覺。當時年輕,沒有睡 午覺的習慣,沒想到每天睡午覺哪怕只是15分鐘, 也可以提高下午的工作效率,同時對身體健康也會有 幫助。美國睡眠專家Jeff
二)郊外一遊:有大學做過研究,將兩類人劃 分成到郊外走及到街上走,發現去郊外的人的短期 記憶,較去街上的人高20%;去郊外走的人,也確 能改善短期記憶。世界上的人瑞,多數都是生活得 非常簡單,甚至住在深山,這足以證明接觸大自然 越多,壽命特別長。 三)放數天假:好處是能全然放下手上的工 作,專注身體狀況,調適身體需要。有時候真的只 能停下來,才能聽到身體發出的警號。能早點發現 身體狀況的異常,就能病從淺中醫。 曾聽過一位牧者講道,講題是「忙、茫、 亡」。為了要為主走更長的路,就要等候耶和華, 也就是提醒我們要「作息有時」。
然跌倒。」(《以賽亞書》40章 30節) 不過,以賽亞繼續說:「但那等候耶和華的, 必重新得力,他們必如鷹展翅上騰、他們奔跑卻不困 倦,行走卻不疲乏。」(《以賽亞書》40章 31節) 以賽亞提出重新得力的秘訣,就是「等候耶和華」。 到底這是甚麼意思?我相信可以從兩方面來了解:
Rodgers 指出,午睡片刻不 僅可帶來充足的休息,還能讓大腦變得更敏銳又專 注,讓工作表現變得更好,同時也會減少心臟病。

羅乃萱 作家、婦女及家庭工作者。自小夢想當作家,最後夢 境成真,卻在人生中途再起飛,進入服侍婦女及家庭 的遼闊天地,看見上主有愛,人間有情,家庭復合, 正享受這個生命的新境界。 馬不停蹄的生活,沒有空檔的時間表,會讓人身 體疲累。這些年,間中也會出現。 年輕的時候,感覺身體疲累仍會死撐。如多喝一 杯咖啡,告訴自己把事情做完就可以倒頭大睡,硬逼 自己把事情做完。 只是人到中年,狀態不再大勇。身子腦袋累了, 怎樣也寫不出句子來,思想也閉塞了。所以這些年一 碰到要交稿而身體疲乏的話,就寧願小睡片刻才再工 作。當然,有些朋友會選擇吃朱古力,或者出去運動 跑步之類,也是不錯的。 不過,最難搞的是「心累」,就是對任何事情 都提不起勁,伴隨而來的生理徵狀可以是筋疲力盡、 頭痛、失眠、脾氣暴躁、感覺無助無奈等。在社交方 面,更是不想見人,不想交談,把自己封閉起來。 有學者分析,人之所以會心累(或精神耗盡), 是因為對未來的不確定,加上個人的失敗經驗,會讓 一個人被周圍的壓力壓垮了。也有人分析說是工作與 悠閒的界線模糊,讓我們活在一個24小時工作的模 式之中。也有人說是因為社交媒體剝奪了我們的精神 精力,讓我們在不斷瀏覽中耗盡精神。 印象中我的人生也遭遇過一兩趟類似心累的經 歷。還記得在那些難熬的日子,每天上班都是百感交 集,感覺疲累。歸根究底,是因為內心對未來沒有盼 望,也看不清前路。很感恩的是當時有一位姊妹送我 《雅比斯的禱告》,在那些無力甚至「不知怎樣禱告」 的日子,這本書帶來新的力量與盼望。 如果往內心探索,可以發現是內心那些控訴絕望 的自白,讓我們陷入深深的心靈迷霧之中。這些控訴 可以是: 我又錯了,都是我的問題。 我的失敗因為我沒盡力。 我怎麼總是這樣愚蠢? 我為何一次又一次信錯了人? 我為何一錯再錯,重蹈覆徹? 這些控訴形成了一個不休止的循環,除非我們 「喊停」。對,就是「喊停」,拒絕這些說法,對它 們說不,或反其道思考:如失敗因為我沒盡力,不如 反思「我其實在這工作上付上了很多心力」。 另一個有效的方法是退而求其次,就是明白事情 不如我們想像計劃,甚至經歷失去失落,但可以退一 步才看見海闊天空。世界之大,機會之廣,是我們退 一步才看得清楚的視野。 在這關口上,最重要的是阻止無止境的胡思亂 想,因為這只會讓人陷入癱瘓的絕望中,無法跟其他 人建立真實的關係。 但請相信:只要我們願意靠着聖靈的禱告,對這 類思想喊停之後,內心就能重拾平靜安穩啊! 安息 心累與身累






















生活文化 ‧鐵窗筆語| TEXT / 衛以信 ART / JL 生 74 苦難源於試探,但不僅限於試探,還有其他原因。有一個原因 對人們來說可能比較殘酷,但卻是不爭的事實——苦難是為了榮耀 上帝。上帝的榮耀,竟然是從人的痛苦而來?驟耳聽來,真的比較 難接受。 由於疫情關係,獄中很多活動都被取消了。活動被取消最直接的 結果就是時間多了,「口爽爽」應承幫一位牧師為他的書翻譯成英 文,共17章,到目前為止完成了11章,希望可以在未來幾個月完成 所有篇章,好讓他可以快些出版。為他翻譯第10章時,剛好看到師 母在多年前患上癌症的經歷,由於要接受放射性治療,她不能上班, 需要申請很多假期。很明顯,年假也好有薪病假也好,都不足夠讓她 接受治療。然而,令人感動的,是她的同事竟然願意將假期捐贈, 讓她在工作上沒有後顧之憂,這是上帝的愛的彰顯。師母繼續分享, 說她感到徬徨恐懼,一個愛上帝的人,到了一處夢寐以求的玫瑰園, 但卻要失去了。然而,一日她聽到牧師講道,是有關克服困難的,他 說:「無論你生活中發生了甚麼,你仍得繼續活下去,而如何度過日 子,是由你自己決定的。」透過這篇講道,師母明白到,有些事不能 人為控制,有些事卻可以控制在手的。這也是我一直以來面對事情的 態度,將事情釐清為:是否可控?完全不可控?還是部分不可控?完 全不可控,就不是自己有能力改變,可以拋諸腦後。如果只是部分可 控部分不可控,便會將可控部分做到最好,將不可控部分交給上帝。 這樣,我可以無悔地說已盡力,讓上帝成就便可以了。師母明白了這 個自己可以控制如何度日的道理後,便一改負面的心態及情緒,轉為 積極面對她的治療,上帝的話語讓她堅強起來。 感謝上帝,接受放射治療後師母真的痊癒了。一晚師母收到 一個電話,來電者是一位患癌的女士,她在師母的見證中知道了師 母患癌的經歷,所以冒昧致電給師母,在對話中,該位女士很徬 徨,很驚恐,因為她也患上了癌症,覺得好像失去一切、失去希望 一樣。當時已到了睡覺時間,師母要為了有足夠精神應付明天的工 作,婉轉告訴她明天再跟她詳談,還是不顧精神狀況而繼續傾談 呢?師母知道現在是該女士最需要她的時刻,於是告訴自己要現在 榮耀上帝 分別為聖──















談,因為這是關乎生死,要幫助她減少憂慮。於是, 師母選擇了與這位女士一直詳談她戰勝病魔的經歷, 直到深夜。這是上帝的愛,上帝的榮耀的投影。 「門徒問耶穌說:拉比,這人生來是瞎眼的,是 誰犯了罪?是這人呢?是他父母呢?耶穌回答說:也 不是這人犯了罪,也不是他父母犯了罪,是要在他身 上顯出上帝的作為來。」(《約翰福音》9章2-3節) 苦難源於試探,但不限於試探。有時候,苦難是 為了彰顯上帝的榮耀。對我來說,入獄算得上是一生 中最大的挫折、最難過的苦難。入獄之初,我腦中經 常浮現很多問題,我不明白,怎可能明白呢?我雖不 能說是善良的人,但也不能說我是壞人、惡人。走過 街邊見到乞丐,我有布施;見到婆婆過馬路,我會扶 她一把。有甚麼可能會坐監呢?所以,在入獄之初, 我常抱着憤世嫉俗的心態,在監獄的日子就是苦難中 的苦難。 我入獄了,我的人生沒有了,然而,上帝卻讓我 在這苦難中,在這人生的低谷中,成長起來。上帝讓 我在祂身上明白自己道德觀、價值觀的崩壞,原來我 之所以要入獄,並不是偶然,而是必然。正如我上期 講到,我的道德底線就是沒有底線,入獄只是遲早的 問題而已。上帝也讓我在獄中反省起來,明白自己性 格上的不足。在明白了後,追蹤過去,找到形成這些 不足的成因,知道自己這部人生列車,就是在青少年 時期開始脫軌,同時亦有了一份感召及承擔,立志要 好好事奉青少年,尤其是問題青少年和邊緣青少年, 只要有人拉他們一把,他們的人生可能就會出現極大 的轉機。有了這份覺悟後,我便開始進修,第一個學 位是修讀心理學,第二及第三個學位都是教育的。我 想,我可以明白他們的想法、感受、遭遇,盼望以我 的知識及經歷,可以成為他們的扶手棍,在適當時機 撐他們一下。這是我的心志,我在獄中也一直以這個 目標為方向而努力,願榮耀歸於上帝。 我立志在出獄後好好事奉上帝,然而,一位姊妹 卻給我一記當頭棒喝:「事奉上帝為甚麼要留待出獄 後?任何時候都可以事奉上帝。」就是因為這句話, 我開始在獄中、在囚友弟兄間做着牧養工作。事有湊 巧,2016年前後,我收到一本《天使心》月刊,翻 閱下覺得很有意思,於是便「膽粗粗」寫信給《天 使心》月刊毛遂自薦,希望《天使心》月刊能夠給 我一個筆耕的地方,可以事奉上帝。結果一寫便寫了 六年,在這六年中,有很多點點滴滴跟大家分享,亦 感謝很多讀者電郵給我,當真鼓舞了我,近日更收到 以前接洽我的編輯陳靜怡小姐的電郵,告訴我原來我 的分享透過《天使心》月刊,在北美地區也有很多 讀者支持和鼓勵,這更令我相信,我所做的並不是無 用,而是真的可以祝福更多人,榮耀上帝。我的苦難 從我的污點而來,然而上帝就用祂的大能,竟然因我 的污點作為祂的榮耀,誰能想像得到、理解得到呢? 苦難源於試探,但不限於試探,苦難是為了彰顯 上帝的榮耀。 作者簡介 衛以信是一名在囚人士,現於赤柱監獄服刑。年 少時犯下大錯,長年被囚在鐵窗之後,上帝卻 釋放了他的心靈。他立志奉獻一生事奉上帝, 《天使心》是他以文字事奉的一隅之地。 如讀者想與衛以信聯絡,可電郵至: wilsontsang0301@gmail.com






隱白穴 地機穴 炭類止血藥 黃啟文醫師 擅長運用中醫傳統經方及針 灸,專門治療婦科病,內科 病及痛症。推崇生活保健, 榮神益人。 生活文化 ‧大夫在線| TEXT / 黃啟文 PHOTO / 互聯網 ART / JL 76 見於月經之後。主要因「虛」、「熱」、「瘀」三 個情況去考慮。 「虛」,因為素常工作操勞過度、思慮過多、 飲食不節、房勞所傷或產育過多等,引起脾虛和腎 虛。中醫上「脾統血」,脾能統攝血液,脾虛則統 血失職,脾氣下陷,血失固攝,下行崩漏。「腎主封 藏」,腎負責身體所有封藏的功能,封藏失司, 腎虛精虧,衝任不固,經血不收,都能構 成血崩漏下。症狀多伴有頭暈、虛浮、 疲憊乏力、面色和唇色淡白、氣喘、 心悸、四肢冰冷、腰酸膝痛等。 「熱」,因為情志鬱鬱不舒,肝 氣不能條達,氣行不暢,氣鬱生熱, 又或平素經常進食熱氣和濕熱食物,如杧 果、菠蘿、煎炸食物等,身體體質偏熱,血熱 血漏指陰道異常出血不止的一種疾病,類近西醫 的「功能性子宮出血」。在中醫婦科病學上稱「崩 漏」。套用現時社會,試想一下,這是一個十分不 方便和十分容易出現尷尬情況的疾病。例如,當上
是身體出現問題,所以必需正視。 西醫學上「功能性子宮出血」是由於內分泌系 統失調,在並沒有懷孕、器官實質性病變及藥物影響 下,卵巢功能障礙引起的陰道出血異常。分「有排 卵型」及「無排卵型」。「有排卵型」多見於育齡 期,因卵泡發育不良或腦下垂體功能障礙,黃體功能 不足,產生黃體期縮短或黃體萎縮不全的表現,而出 現異常出血。「無排卵型」多見於青春期或更年 期,因雌激素持續分泌,在沒有黃體素的 配合抑制下,子宮內膜會持續生長,脆 弱而易出血。 中醫學上稱「崩漏」,「崩」 指經血突然大下不止,「漏」指經血 仍然滴滴答答、綿綿不停、淋瀝不盡。 「崩漏」雖然並不局限於是否行經時期, 但臨床上「崩」多見於行經期,而「漏」多 《路加福音》記載了一段關於患血漏病的婦人,耗盡積蓄到處 求醫,卻因信心而得醫治的經文。甚麼是血漏病? 血漏的婦人—— 談中醫治療「崩漏」
班開會中,突然血崩而出,量多至弄污衣服;朋友邀 請聚會,卻因經血淋瀝不盡而頭暈不適,只能婉拒。 雖然這和古時猶太社會視血漏為不潔的原因不同,但 在現時社會下絕對也會影響日常和社交生活,更何況



阿膠 妄行,而致崩漏。症狀多伴有面赤、舌紅、煩躁、鬱 悶、大便不暢、口乾口渴。 「瘀」,指血行不暢而阻滯,情況較為複雜。可 以因過食生冷,因寒而瘀;可以因過食煎炸,因熱而 瘀;可以因情志不舒,氣鬱而瘀。當「瘀」出現後, 會阻礙正常的血行,而出現血只能妄行而下的崩漏。 症狀多伴有小腿皮膚乾裂甲錯,舌有瘀斑,經血暗 紅,血塊甚多。 以上三者,臨床往往不會單一出現,多會互相 兼見,只要掌握以上三者情況,崩漏是可以治癒的。 治療上西醫往往用上口服避孕藥減輕症狀,甚或進行 子宮內膜刮除術;中醫會有策略地分三個階段進行: 一)「塞流」:即止血,在出血期間,急需止血防脫; 二)「澄源」:澄清本源,找出原因,辨證治療;三) 「復舊」:善後固本,補益氣血。「塞流」會先處 方中藥止血,如阿膠、炮薑、地榆、艾葉,甚或炭類 止血藥。有需要時也會用上針灸治療,會選用 血海穴、地機穴、隱白穴等。「澄源」, 就是當出血量減少時,針對「虛、熱、 瘀」的情況去處方中藥,解決身體體質 的問題。「復舊」以「補脾腎,益氣血, 調肝氣」的方式,鞏固治療。 一)香港社會節奏急促,需要注意休息,避免 熬夜,勞累過度。 二)喜樂的心乃是良藥,保持心境開朗,切勿 思慮過多。 三)保持情緒平和,不輕易發怒,以免肝氣有 損。 四)平時飲食定時定量,不要食無定時,遠離 煙酒,損傷脾胃。 五)注意房事,不可過多,縱慾過度。 六)切忌偏食,過食生冷,如刺身、凍飲、西 瓜。 七)遠離煎炸辛辣的食物,如欲中藥進補請先 諮詢註冊中醫師。 八)適當鍛練運動,令氣血暢通,瘀血不生。 九)如遇上其他月經的問題,應該及早治療, 以防發展至崩漏。 預防「崩漏」的方法也是針對「虛」、 「熱」、「瘀」三個情況去考慮:
會左耳入右耳出,很快就會忘記所學的。


2000年,公司送我到哈佛商學院接受七個星 期的培訓,每晚都要和同學一起討論教授分派的個 案,這些個案都是商業運作的問題。第二天早上要爭 取發言的機會,發言越多教授給分越多。當然發言內

生活文化 ‧治強不息| TEXT / 紀治興 PHOTO / 互聯網 ART / JL 紀治興 太平紳士,豐盛社企學會會長。 浸會大學工商管理學院客席教授、 伯特利神學院城市宣教學客席教授。 今年去了三間相熟的教會崇拜中講道,講題都是韋爾比所鼓吹的信徒要有勇氣,勇氣包括⋯⋯ 對成人有效的學習方式, 當中有四點:一)成 人只學他想學的東西;二)成人的豐富經驗藏有實 用的智慧;三)成人喜歡表達意見;四)成人在聆 聽講師的論述時,要整理論述中的材料,要如何配合 自己的需要。若果沒有花時間篩選、潤飾及整理,就
容質素亦影響分數。哈佛商學院要學生透過分析個 案,學習、累積經驗和建構符合自己的知識。哈佛商 學院以分析個案的學習方法極之成功,其他大學亦採 取這種教學方式。 近年我在不同的神學院教轉化理論,頭兩班學 生的反應一般,到第三班我嘗試參考哈佛商學院的方 法,重點是讓學生主動學習。開始上堂時,我會就 當晚的主題教10-20分鐘,然後叫同學分為四至五人 的小組,彼此分享意 見。30分鐘後,叫每組派代表 分享同學們的觀點。當中既有師生間及同學間的對 話。第三班的同學個別表達他們很享受這種小組主動 學習的方式。 第四班完結後,部分學生分享他們的學習心得
中,鼓勵會眾分為四至五人的小組,彼此分享意 見,踴躍發言。 講道內容應該帶出新觀念,例如經文新釋,譬 如《傳道書》所講的虛空,多是可以用錢買來的樂 趣,容易獲得,亦容易忘記。這種易趣沒有長遠價 值,所以是虛空,信徒應該捨易取難。 難趣是用體力、心力、努力去換來,難以獲 得,亦是難以忘記。新的習慣如積極勉強自己做應該 做、懂得做但不想做的事,從而脫離安舒區。新的行 動如抱負和爭勝,大部分信徒每星期聽道,但多是左 耳入右耳出,這種現象是因為不懂得學習科學,首先 是講道內容不吸引,另外是講員不懂得生活信仰化及 信仰生活化。 以學習科學的方式在崇拜講道 生 78
時,指出個別教授在堂上只是讀筆記,學生只能被動 地接受教授的陳述,而沒有小組主動學習的方式。 若果講道內容吸引,可以叫同學分為四至五人的小 組,彼此分享意見,然後叫每組派代表分享。 今年去了三間相熟的教會崇拜中講道,講題都 是韋爾比所鼓吹的信徒要有勇氣,勇氣包括:人生 有抱負、一生不枉過、要有創意、創造新的事物、 克服困難,最後是爭取今天比昨天好。講道的過程



















本校網頁: www.hkicc.edu.hk | Email: info@hkicc.edu.hk | Tel: 2770-3669 九龍塘校舍:九龍塘廣播道4號南亞路德會大樓三樓 | 旺角校舍: 九龍彌敦道736號中匯商業大廈6樓601室 5998 3376 情緒支援熱線 5509 5658 恭賀「香港基督教輔導學院」 第十五屆畢業典禮 Bachelor of Christian Counseling (BCC) Master of Christian Counseling (MCC) Postgraduate Certificate in Christian Marriage and Family Therapy 「網絡沉溺的生態與病態」短期課程 上課日期:2023年1月4日、11日、18日(逢星期三,一共三堂)












生活文化 ‧綠色管家| TEXT & PHOTO / 余遠騁博士(世界綠色組織行政總裁) ART / JL 世界綠色組織簡介 世界綠色組織透過以科學為本的 政策研究,深入完善的社區工作,與公眾分享研究成 果,提出建議,旨在提升環境質素、改善市民生活、 加強市民環保意識,並推動綠色經濟。同時,世界綠 色組織會就社會各階層,尤其弱勢社群的生活需要, 推出與環境相關的扶貧項目,回應因環境變化而引起 的社會矛盾,創造綠色經濟機遇,落實可持續發展的 願景。如欲了解本會工作,請到 本會網頁查詢:www.thewgo.org 未受影響,再加上每天可回收三噸紙包飲品盒、十噸 雜紙的全港唯一紙包飲品回收廠「喵坊 Mil Mill」將 在年中租約到期並需要遷出科技園,廠房未來可能轉 移至新加坡,雖然事件在社會引來熱烈討論及廣泛回 響,仍未能阻止本地回收又走回頭路的事實。 垃圾徵費即將在今年出爐,以「污染者自付」 原則「按袋」或按重量收費,原意除了是鼓勵社會 實踐源頭減廢,也要做好分類回收,但若然得不到回 收政策及配套的支援,回收物不知何去何從,恐怕整 體垃圾量不會見明顯下降,因此綠在區區的成立並鼓 勵市民轉用社區回收設施和服務就更顯重要了。 第 27 屆聯合國氣候大會(COP27)於上 年11月完結,其中一個關注點是達成了發達國 家對發展中國家的就氣候變化造成經濟損失的資金支 援的「歷史性」協議,被視為可能是自《巴黎協定》 後的最重大的進展,可見世界對氣候變化等環保議題 的重視。回到香港,踏入 2023年,讓我們回顧過去 一年的本地環保焦點。 象牙及象牙製品取自死去的大象,「有價有市」 的象牙貿易更促進了大量的非法捕獵活動,每年有超 過三萬頭大象被殺害。地球現存的四種大象——非洲 草原象、非洲森林象、亞洲象和婆羅洲象中,就有三 種被世界自然保護聯盟( IUCN)列為瀕危物種或極 危物種。 現時銷售及擁有象牙已在大部分國家被立法禁 止,香港亦終於在 2021年12月31日全面實施禁象 牙貿易條例,象牙只可作個人收藏及展覽等非商業用 途,而古董象牙製品和已絕種的長毛象牙製品則可獲 豁免,唯仍難阻止走私活動及以魚目混珠的手法將新 象牙扮成古董象牙繼續銷售獲利,望政府能加強市場 巡查及打擊走私活動之餘,在香港亦能逐漸培養更環 保、零殘忍(Cruelty-Free)的消費文化。 雖然「藍廢紙、黃鋁罐、啡膠樽」的口號耳熟 能詳,但香港的回收率一直未如人意,三色回收箱的 成效更是為人詬病,隨着綠在區區的成立及推廣, 香港的回收之路彷彿出現了一道新的曙光之際,原來 熟悉的三色回收箱正逐漸被淘汰。現時全港約有一萬 八千套回收箱,管理全港一成的回收箱的環保署自上 年6月已逐步撤走路邊回收箱,並指今年路邊回收箱 將「絕迹」,其餘受其他政府部門管轄的回收箱則 路邊回收箱「無得留低」,在今年全面撤離。(圖片來源:明周) 2023年環保能否 說好香港故事? 生 80





陳國平博士 美國教牧學(城市領導)博士、香港心理中心總監、 美國臨床心理學博士、美國婚姻與家庭研究博士、 美國婚姻與家庭治療碩士、美國神學及心理學碩士、 美國教牧學碩士、基督教研究輔導碩士、美國心理學會會員、 香港心理學會註冊心理學家,曾任衛道神學研究院院長。 生活文化 ‧心靈解碼| TEXT / 陳國平博士 PHOTO / 互聯網 ART / JL 告別憂慮的「4+3」良方 耶穌在《馬太福音》6章尾段提醒門徒不要為明天憂慮:吃、喝、穿甚麼?一天的憂慮一天當就 夠了! 過去三年,全球疫症猖獗及地緣政治危機使全球 經濟陷入衰退,嚴重地危害無數人、家庭和社群的活 動和生態!無力、無助和憂慮,可說是當代人的寫照
關注等。耶穌曾多次提醒門徒「不要為明天憂慮」, 《腓立比書》4章6-8 節為我們提供了四種轉憂為樂的 方法: 一)凡事禱告——敬拜讚美上帝:唯有承認自己不是 上帝,只有那全能至高者才是上帝,就如耶穌教門徒 禱告,開始便稱:「我們在天上的父,願人(包括自 己)都尊袮的名為聖。」我們先要全心敬拜尊崇祂, 確信祂是全能愛護我們的天父,就能把重擔卸給祂! 二)逼切祈求——求上帝憐憫:我們要放膽,逼切向 上帝祈求甚至乞求!就如迦南的婦人向耶穌乞求醫治 她的女兒,最後耶穌動了慈心,垂聽這個外邦女子的 懇求! 三) 凡事感謝——信上帝必賜最好:這裏的感謝是 指,無論是禱告(敬拜)或祈求(乞求)都帶着感 謝的心,相信上帝會賜最好的給我們!我從事心理治 療多年,很少見到極度憂慮的人能從心發出真摯的讚
明天憂慮:吃、喝、穿甚麼?一天的憂慮一天當就夠 了!提醒我們: 一)「每天盡本份」努力做好預先計劃要做的工作, 不要為明天憂慮!因為過分的憂慮只會危害我們的生 命健康。 二)當憂慮來到,我們可「親親大自然」,看看野地 的花、天空的鳥,上帝尚且照顧,何況我們是天父所 愛的兒女!當人與大自然親近,體內的快樂荷爾蒙, 尤其是血清素就會增多,令人減輕憂慮! 三)「把焦點轉移」,不要專注自己,反要先求上帝 的國和義,我們所要的東西上帝都會賜予,而且加倍 賜予! 憂慮是一種情緒的反應,《聖經》常常命令我們 要喜樂。喜樂和憂慮是可以選擇的,喜樂的心便是良 藥。但願大家能夠透過《聖經》的教導,用告別憂 慮的「4+3」良方,在新一年活得更喜樂開心! 生 82
和悲哀,《聖經》有何解救良方? 「憂慮」在《聖經》出現了19次,其中六次在 新約出現。「憂慮」的希臘文是由撕裂和精神思想兩 字組合而成,簡言之,憂慮就是把人的思緒和生活撕 裂。嚴重的憂慮使人心神恍惚不安,難以入睡。「憂 慮」的原文也有譯作擔心、掛慮、焦慮、煩躁不安或
美和感恩;相反,充滿讚美和感恩的人也很少會陷入 極度憂慮中。 四) 告訴上帝——詳細陳述:有次一位富商專程乘 飛機來求診,分享他辭退CEO的職位後,大小事情 都要親自安排管理,因而十分憂慮不安。我請他寫下 所有可行的方案及聘任人選,當晚他睡得很甜,隨即 啟程回國。詳細列明,並向上帝陳述-切,亦有治療 作用。 耶穌在《馬太福音》6章尾段提醒門徒不要為



生活文化 ‧志英理財| TEXT / 曾志英 PHOTO / 互聯網 ART / JL 曾志英 資深財經傳媒工作者,《人生交叉盤》及 亞視《曾 Sir 28 騷》主持人。 從肥媽經歷談2023理財態度 套息交易最基本定義是指借入低息貨幣,並買入高息貨幣(計價資產),而兩者之間存在息差, 就是套息交易所要套取的「息」。 肥媽早前自爆了一件慘痛經歷,原來她早幾年前 已經打算退休,但由於「炒燶」股票輸 近5,000萬 元,加上老公患重病需要支付高昂醫藥費,令她感到 上天要自己繼續工作。從肥媽的經歷,就知道投資理 財有幾重要,許多專家都認為 2023年投資市場將會 十分波動,大家要打醒十二分精神。 肥媽指當年是誤聽朋友講,未有做好功課,將大 部分退休金買入三四線股,或稱為蚊型股,風險與承 受能力錯配下,受到了一次沉重教訓! 也許你已經很 smart,只是將錢存入銀行收息, 但依然可以徒勞無功。早前筆者見港元定期利息高 達4厘,義無反顧做了定存,但期間銀行投資經理力 說轉換美金,以套取美元高息,原因是美國聯儲局 連續加息,港美息差擴大,而且 2023 年仍有可能繼 續加,在聯繫匯率制度下,容易吸引「套息交易」 (Carry trade),一方面賺取美元高息,另方面也利 用美元強勢來賺錢,因而令許多資金流出港元流入美 元,理論上,投資者可以透過轉換美元財息兼收。 早前港匯持續弱勢,其中一個原因便是套息交易 活動所致,港元一度跌 至7.85 弱方保證水平,金管 局多次承接港元沽盤,以保衛聯繫匯率。 套息交易最基本定義是指借入低息貨幣,並買入 高息貨幣(計價資產),而兩者之間存在息差,就是 套息交易所要套取的「息」。值得注意的是,套息交 易除了可以賺取差價外,當高息貨幣升值時,亦會賺 取匯兌收益。在主要貨幣中,日圓為最常被用作套息 的貨幣,主因日本長期奉行超低息政策。 因為聯繫匯率的機制使然,香港利率走勢大概會 緊貼美國利率走勢,若有太大的利率差距,市場自然 會進行套息交易,買進港元或美元兩者間較高息的貨 幣,而借入較低息的貨幣以增加其槓桿效應。原因是 市場相信,整個強方兌換保證與弱方兌換保證的差距 只不過是1.28%,就算賺息輸價,只要息差足夠大, 其受傷程度亦有限。 走筆至此,大家一定以為筆者已經做了「套息 交易」,其實當時筆者一口拒絕,原因不是「嫌錢 腥」,而是港元已經跌至7.85,金管局勢必出來保衛 港元,已沒有太多下跌空間,銀行經理當然希望你會 做「套息交易」,因為一買一賣已經穩賺你的差價, 至於所謂美元高息,扣除買賣差價已經打了折扣,更 何況港元最近已回升 至7.78水平,投資者在匯率上 又蒙受損失,換言之,到頭來只是「運桔」!
聖誕日向前推一個月,教會訂為「將臨期」(Advant),即預備 迎接耶穌基督的來臨。通常由聖誕前第四個主日計起,稱之為「將臨 期第四主日」,然後如此類推,直至最接近聖誕日的那個主日。 有一段經文是將臨期必讀的,是《馬太福音》24章36-44 節,裏 面提到主再來的日子無人可知,但警惕我們要認真作好準備,否則就 像昔日挪亞時代洪水猝然而來,世人措手不及,結果被大水冲去。而 經文中有幾句說話,聽來耐人尋味,有點兒大惑不解。 「那時,兩個人在田裏,一個被接去,一個被撇下;兩個女人推



生活文化 ‧思苦後甜| TEXT / 吳思源 PHOTO / 互聯網 ART / JL 吳思源 資深文字工作者及心理輔導作家。 從心會社創辦人及社長,完美句號事工行政總監。 著作廿餘種,包括《馬大的腳馬利亞的心》、 《願作人間照夜燈》、《從小學到大》、 《教孩字面對風暴》、《教孩子創造未來》等。 生 人生常作準備 究竟兩種完全不同的待遇,背後有甚麼原因?是運氣?是以前積下的功德?是上帝任意的選擇?
磨,一個被接去,一個被撇下。所以,你們要警醒⋯⋯」 究竟兩種完全不同的待遇,背後有甚麼原因?是運氣?是以前積 下的功德?是上帝任意的選擇?究竟「被接去」和 「被撇下」背後 原因的分別又是甚麼? 其實解釋就在這段經文的後續(《馬太福音》25章1-13節), 耶穌所說十個童女的比喻。在暗夜裏守候新郎來臨的共十童女,但當 中只有五人作好準備,預備了更多的油,當黎明前提着的油燈耗盡了 油,還有油可添,使燈仍亮,直等到新郎來到。 「將臨期」提醒我們,要為主再來和之前必遇上的危難和陣痛作 好準備。「作好準備」未必會減少痛楚,卻可使我們有充足的信心和 力量去承受痛楚,並且知道有一天黑暗終會過去,天亮必會來臨。 84



生活文化 ‧我有話說| TEXT / 查錫我 PHOTO / 互聯網 ART / JL 查錫我 查錫我,前廉署總調查主任, 現職執業大律師。肝癌倖存者。 少貧,十三歲當洋服店學徒, 信奉基督和終身學習。 快樂的追尋(二十八) 一方面,他的想法讓他不快樂,但是他又不願意放下讓他不快樂的想法,這是十分矛盾和難以理 解的。 上期談到要不執着和謙卑,並要學習用心聆聽 別人的看法,這樣才可以減少爭拗和煩惱。如果我們 可以放下執着,就可以得到自在,保持心境平和。
快樂的想法。可是,很多人來找我輔導,一般都是感 覺不快樂,很想我幫助他離開痛苦,得到快樂。 問 題是,很明顯他不快樂的根源就是他的想法。一方 面,他的想法讓他不快樂,但是他又不願意放下讓他 不快樂的想法,這是十分矛盾和難以理解的。我一般 都會把這個矛盾告訴他,請他好好想一想,他到底要 抱着讓他不快樂的想法不放,繼續不快樂下去,還是 嘗試先把讓他不快樂的想法放下一會,看看有沒有其 他可能性。 舉個例子,有一位剛剛大學畢業,初出社會工 作的年輕人,在父母要求下來找我。面談時他說覺 得同事總是在針對他,而且在他的上司和同事面前 講他壞話,弄得他不想上班,每次回到辦公室都神 經繃緊。因此,他的結論是,他不快樂的根源來自 同事,他問我有甚麼方法可以改變。我要他想一想: 為甚麼他的同事會針對他?他說因為他較其他同事聰 明和效率高,因此他常常得到上司的讚許,同事都妒 忌他,講話時總是單單打打,說他驕傲,看不起其 他人。 他問我,難道工作做得好不對嗎?是他的問 題,還是同事的問題? 我跟他說,把工作做好當然沒有不對,問題是 我們爭取工作表現時有沒有考慮過同事的感受和想 法。他一臉茫然,好像不明白我的意思。我於是跟他 說,同事在公司做得較他久,已經適應了公司的文 化,他是一個新人,表現較他們出色,他們感覺受到 威脅,自然想辦法聯合起來把他壓下去。他問我應該 怎麼辦。我跟他說,在職場把工作做好不容易,可是 把同事之間的關係搞好更不容易。關鍵是,首先是別 一開始就要分誰對誰錯,我們只需要經常留意同事關 係的重要性。當上司讚賞自己時要學習謙虛,把功勞 分給其他同事,說都是同事的教導和提點。此外,嘗 試別做獨行俠,多點參加同事的活動。聽後他恍然大 悟。後來聽他父母說,經過一段時間,他已經適應了 工作環境,人也顯得開心得多了。
我們想快樂,就要不執着,但是到底甚麼是執 着?執着就是把我們的觀念或想法抓住不放。假如我 們的想法可以讓我們快樂的話,當然應該堅持讓我們



生活文化 ‧還富於文| TEXT / 司徒永富博士 PHOTO / 互聯網 ART / JL 司徒永富博士 鴻福堂集團控股有限公司總經理兼執行董事 香港專業人才服務機構主席 著有多本管理學及心靈書籍, 包括:《老闆要的不是牛》、 《唔緊要─心中有富的人生智慧》、 《教曉員工高飛─風箏管理學的5P魔法》 生 躺平在主的臨在 最近我參加了一個線上講座,題為:「上帝我不想努力了!」其中很深刻的一個觀點是:「躺平 沒有問題⋯⋯某種程度是一種正面的事情。」 執筆之時,正是 2022年年底,迎向耶穌基督的 降生,進入將臨期的第二周。當下大環境仍是充滿挑 戰、人心散亂,以下幾句說話節錄自社交媒體,道盡 了不少人的心情: 「 天下無難事,只要肯放棄; 好好活下去,天天都有新打擊; 你必需非常努力,才能相信自己無能為力; 只要用錢能解決的事,我一件都解決不了; 努力不一定會成功,但不努力一定很輕鬆; 在哪裏跌倒了,就在哪裏躺下來。」 牛津大學出版社亦票選了年度詞語,「哥布林 模式」(Gobin mode )為第一熱詞。哥布林模式在 歐美網絡走紅,意指一種自我放縱、懶惰和邋遢的生 活表現,與我們常接觸的「躺平」和「擺爛」有類 似意思。這突顯不少人(尤其年輕人)並不想回到 疫情前的生活模式,或是反抗社會加諸他們身上的理 想、過積極人生,寧願及時行樂。 最近我參加了一個線上講座,題為:「上帝我 不想努力了!」其中很深刻的一個觀點是:「躺平沒 有問題⋯⋯某種程度是一種正面的事情。」和一個分 享:「現代許多職場基督徒被過度消耗。職場如殺戮 戰場,而教會就像營地,當經過辛苦廝殺後,基督徒 返回營地想修整裝備,卻看到營地東牆破、西牆漏, 亟需人手修補;但還未休息,又再度投入服侍,導致 長久下來身心俱疲。」這的確真實地道盡現今信徒的 內在處境,可惜不少信徒(尤其是職場信徒)的經
霧也越大,前路很模糊,在我腦海悠然浮現出一道聲 音:「你要休息,要知道我是上帝!」 執筆之時,也正度過了位於大嶼山神樂院四天 三夜的靜修。平時每天想着改變世界的我,行事曆總 是填得滿滿的,也樂此不疲地宣講大道理,也真的佩 服自己可以大部分時間在院內禁語,跟隨修士一天七 次禱告(其中更課是在半夜3時30 分和晨禱在早上6 時),和與其他修習者一起在山間清除雜草。從退去 到安靜、操練專注,到重拾規律的生活節奏,我經驗 了真正的自在、簡單,貼近上主的臨在⋯⋯對,就在 此時此刻的臨在。口中不期然常哼着泰澤詩歌:「不 再有憂慮,不再有害怕;與主在一起,甚麼都不缺。 不再有憂慮,不再有害怕;有主就滿足。」 很感恩,能有片刻的退去,從散亂的心情,轉化 到「有主就滿足」的幸福感,迎向2023年。 86
驗還是「不被聆聽」,不少信徒至終的反應就是「自 謀多福」。 以我為例,近年特別看重「退去」、「安靜」 的操練,其中很生活化的操練就是恆常退到山間享受 「森林浴」、靜聽天父的「微聲」,與創造主結連。 記得有一趟,來到陡斜的馬鞍山──當爬得越高,



黃兆輝博士 香港幸福安老協會主席 EcoHealth 首席科學總監 香港大學客席副教授 挪亞方舟前館長 廣州人民法院及全國婦聯調解顧問 城大校友會主席、前港大法學碩士LLM校友會主席 生活文化 ‧解毒研究所| TEXT / 黃兆輝博士 PHOTO / 互聯網 ART / JL 總會⋯⋯再見 牧師,多謝你在港時,常來探望,常予意見,和真誠的分享,沒有後悔跟你見上一些人,聽一些事, 領略真人見證,點點滴滴累積了不少。 牧師,真好,終於收到你 WhatsApp 的長長訊 息,一直也沒有問你甚麼時候回來,心底知道你一定 有難言之隱。「回來」是假設了你的家和方向,其 實,誰知道我們自己明天在哪?當然,這段日子你為 甚麼無言?也許是因為現在身邊的朋友?在港你曾經
你估不到自己今次一去未返?放鬆些,若果錢 財是很多人放不下的,而牧師你近十幾年來,離開高 薪厚職,早早看得開,這麼,你如今為了甚麼?成就 感?我相信主耶穌要你所做的,早就不是你預知道 的,所以, 哪裏有需要,就往那裏去! 為甚麼要留在他方?有甚麼大事要辦?要幫甚麼 兄弟姊妹?其實,你今日無言,是的,種的樹,沒有 果,甚至未見到一丁點花蕾! 是的,人有限制的,一生有限時間,有些人是站 在上兩代人,甚至不曾認識的人的肩膀上(不管是家 族爺爺、公司的前任⋯⋯),總之「工作升降機」「成 果號」就是遇上他,不是他建立,到今日,大家大概 也應該看得懂。然而在上主的計劃中,有時是我們不 上船,或偏偏想提早下船,無論遁水路、陸路,在路 上,對喜歡幹事的人,總會有一些有意義的活動,只 是尚且未見聚沙成塔的日子臨到,我們便帶着一些人 或記憶,走到下一處⋯⋯仍是會有更多人和事,但是 你做的事情仍繞着一個人——主耶穌,多好運!很多 人一生都不知繞着甚麼而勞碌,向北飛向南飛呢? 牧師,多謝你在港時,常來探望,常予意見,和 真誠的分享,沒有後悔跟你見上一㘹人,聽一些事, 領略真人見證,點點滴滴累積了不少。或許,東奔西 跑,不見得成了甚麼大項目大成就,但,仍然感恩事 工路上遇上,發光發亮,誰在幫誰也未說定,過去在 苦困中疫情下,總算有些人更真誠相交,成為福音方 陣的前後左右。 香港劇變,再加疫情三年後,一切又將是新 一頁,前路誰知道?人們移出移入、西遷北上或留 下,成了新常態。確實在工作圈、睇波朋友圈、團 契也好,聖誕花依舊,人面不知何處去,大變仍一 直發生,留港或離港的日子中,遇到的困難,絕不 比之前少,左軚右軚的路,沒有變得平坦,誰不是 也在困惑中嗎?但,有氣息,有能力,已叫我們足 夠,真心感恩。 故事並沒有因主離開而終結,福音並沒有停止在 《約翰福音》21章,很多人在不同土地仍寫下去,牧 師也好,有崗位和無崗位的,也要趕快新釣二魚,新 發酵五餅,為主的準備功夫,我知道你不會停止。保 持聯絡,我們總會再見,祝福你!在港肢體。
擔心的家人和服侍的病人或其他甚麼人的關係,對你 有期望而產生不知該怎麼回答今後去向?



生活文化 ‧開心快樂人| TEXT / 曾北偉 PHOTO / 互聯網 ART / JL 生 當你從正面角度思考,就會產生良好的自我感覺,認可自己的吸引力時,周圍的環境和人事都會 境隨心轉。 萬有引力,是古往今來在物理世界、自然界和生 物界同樣擁有的。比如說,一個人越開心,越會有吸 引力,越容易與他人建立並維持良好的人際關係,越 是容易吸引他人向自己靠近,甚至是陌生人。想起一 個親身經歷的故事和大家分享: 去年夏天一個周日上午,陽光燦爛的日子,我穿 上一身休閒裝,戴着太陽眼鏡去海邊游泳放鬆。在巴 士車廂中有一個靠窗雙人座位空着,信步走過去靠窗 坐下,環顧四周,隔壁的雙人座位也坐有一位先生。 下一站停靠後,上來一位老者,步伐緩慢,一步 一步走到中間過道,在我旁邊的位置坐了下來。 大家都知道現在新冠疫情還是很嚴峻,大家出 門都會戴口罩,並有意保持距離,這已經是習慣了的 出行方式。所以,當老人坐我旁邊時,我很自然會思 考,他為甚麼不坐到隔壁那個空位置?對方身體比我 瘦小,座位應該比較寬敞,應該更加舒服才對,心裏 馬上引起對老人的不滿。 我相信大部分人也會有同樣的反應,感覺自己怎 麼這麼倒霉,為甚麼老人不去選擇隔壁座位,而讓我 的空間變得擠迫,立刻產生負面情緒。 當時我馬上從另外一個角度思考,相信好人會產 生一種氣場,可以讓周圍的人感覺舒服。而老人的選 擇是因為感覺到我的氣場而更認可我,覺得我眼神純 粹,神態輕鬆,他坐我身邊座位感覺好一些。 當我改變了這樣的想法,所有負面情緒馬上一掃 而空。我很自然地主動和老人閒聊起來,經歷了一個
思維方式等,原因是因為人類比較自然地記憶自己做 不好的事情,積少成多,就產生自己的負面定位。 我們每個人都同時掛着多重身份,子女、兄弟 姐妹、伴侶、父母、同事、伙伴等。每個身份都有不 同的工作需要每日完成。由於每日的時間有限,有些 工作會完成,但肯定有些工作未能完成,而我們的習 慣就只記着沒有完成的事情,而忽略了已經完成的事 情。 我給大家建議一個很簡單的解決方法,就是每 天臨睡前,記錄今天完成的大大小小事情。譬如今 天陪子女玩了20分鐘遊戲,看了兩頁書,與幾年沒 有聯絡的朋友通電話,買了一些小零食給父母,走了 8,000步等等。這個動作雖然很簡單,實際上跟運動 訓練一樣,慢慢就會培養出對自己的認可。 相信自己,我們是最棒的。 我是最棒的 88
前所未有的愉快的乘車體驗,而且從對話中有所悟, 也有所得。 當你從正面角度思考,就會產生良好的自我感 覺,認可自己的吸引力時,周圍的環境和人事都會境 隨心轉。 但「自我感覺好」、「認可自己」是不容易的, 大多數人都習慣否定自己,責怪自己的決定、行為、


曾北偉 影音使團營運教練 區塊鏈加密技術科技公司CEO 人工智能物聯網技術公司董事 資深企業管理導師 快樂指數95%人類 變革從來都不會感覺完美的,特別是在開始期間,會受到很多預料之中和意想不到的障礙。 市場每天都在變,企業要在市場上發展或生存, 變革是運營中不可避免的一部分,組織和團隊管理的 變革能力是管理者的核心元素,但大部分人(特別是 企業的老成員)對變革感到害怕、擔心、焦慮和壓 力。如果我們不了解改變的原因,就會害怕改變,就 會抵制它。美國大學做了一個統計,總結了人們害怕 改變的五個最常見的原因。 一)失去 人們害怕改變是因為他們擔心可能會失去和放棄 某些東西。我們是否必需停止專注現在喜歡(並不一 定是對企業最佳)的工作?還是停止與我們喜歡(並 不一定是最好)的人合作?這些人會將職位的改變無 形中視為對他們自尊的攻擊。我們必需理解企業的變 革是完全按照市場的發展,並不是按照個人的喜好。 解決方法:企業必需預測人們會如何回應並傾聽 他們的擔憂,給他們時間吸收變化。要很誠實地告訴 他們企業變革是積極的。 二)混亂 變化有可能對他們來講會導致不確定性,意味着 將人們推出舒適區。因為變革會改變他們的習慣,會 讓他們不安全。 解決方法:解釋清楚企業會如何確保在變革過程 中提供幫助。 三)缺乏能力 變革可能需要用新流程新工具,這會讓他們擔心 原來的技能會否被排擠、他們會否顯得愚蠢過時。 解決方法:變革期間,企業必需制訂團隊需要增 值哪些知識、信息和技能,計劃幫助團隊獲得必要的 能力。管理層要花時間與每個人單獨相處,並鼓勵他 們確定自己的發展需求,告訴他們市場是在改變,企 業要變革,團隊要升值。 四)更多的工作 變革可能會增加工作量,因為變革需要時間,人 們不可避免地必需設計和測試新方法,同時還需要照 常營業。由此產生的工作量會使變革感覺是多餘的。 記着,變革從來都不會感覺完美的,特別是在開始期 間,會受到很多預料之中和意想不到的障礙。 解決方法:變革是長期工作,一定不能一刀切。 必需讓團隊慢慢習慣整個過程,承認他們需要額外的 工作量,盡可能把變革分解為分階段的步驟。 五)失去控制 變革會讓他們失去了對自己舒適區的控制權。每 個人都喜歡擁有控制權,建立他們自己的舒適區。變 革往往改變團隊的舒適區,而讓他們感到無能為力。 解決方法:引導他們從新建立新舒適區,讓他們 有信心能在舒適區裏擁有自己的控制能力。 企業的每個成員必定會對明天的變化做出不同的 反應,也知道企業需要變革,但由於他們自信心不足 而表現擔心、焦慮、壓力等,企業必需讓他們了解, 尋找比較好的流程讓他們容易過渡。 企業的變革——團隊的擔憂 生活文化 ‧開心經理人| TEXT / 曾北偉 PHOTO / 互聯網 ART / JL






喬宏太太小金子 自小在基督教學校學習,畢業後 在電台當播音員,被譽為天使的 聲音。喬太從不間斷身體力行堅 守傳福音的使命。最近以喜樂婆 婆的形象同心同行支持影音使團 各項事工。 銀齡天使心 ‧喜樂婆婆恩典冊| TEXT / 小金子 PHOTO / 影音使團 ART / Andy 90 感謝主, 我又回香港了! 移民美國廿幾年,有人問懷念香港嗎?我都說沒 有,因為經常有回去服侍的機會。最近想回香港了, 「是因為疫情影響太久沒回去,想念香港的 ⋯⋯?」 你別猜了,你猜不着,我是懷念香港的服侍,和香港 的匯豐銀行!」 「吓?」沒甚麼值得大驚小怪的,因為我移民 時,把香港匯豐銀行的戶口交給一個關係很好的主內
情影響到郵政,一個多月後她才收到卡,拿到銀行取 錢,職員說卡太舊了,需要更新。銀行給了我申請 表,好在手機可以傳送文件。填好了送過去,銀行說 簽名不符。我再填寫,再用特快郵 寄,結果仍然被拒,原因還是簽名 不符,需要本人親身去。後來有人 告訴我,其實只要我朋友在我戶口 入一兩百元港幣就好了,可惜我事 後才知道。想起喬叔給我取的花 名:「事後有先見之明!」 兩次簽名不符,辦新卡被 拒,銀行說,我可以到西雅圖匯豐 辦一個海外簽名,只要我當職員面 簽,那就是我的新簽名。好在在西 雅圖上帝給我預備了各種幫我的天 使,一位專幫我辦事的天使知道 我的難處和需要,二話不說,替我安排好約見,陪我 到了最近我家的匯豐。沒想到匯豐的職員也是上帝給 我預備的天使,我當着他的面簽完了字,他說,他會 替我把新簽名寄去香港,和我聯絡的匯豐分行會打電 話通知我,既省事又省郵費,可惜的是他們打來留了 電話號碼,我打去多次,等了很久都沒人接聽。我在
姊妹,前一陣子她告訴我銀行有信,我請她打開, 銀行說我的戶口很久沒動,需要更新。我想了一個笨 法子,把提款卡寄給她,請她拿點錢出來。沒想到疫
想:「要是能回香港就好了!」 心想事成,相信是天上的爸爸感動了香港的創世 電視,竟真的邀請我回港服侍。能回香港把銀行的事 解決已經夠我感恩的了,竟加上祝福,在上帝的聖工 上有份,能不感恩嗎?





















生活文化 ‧愛.閱讀| TEXT & PHOTO / 老冠祥 ART / JL 生 92 老冠祥 記者團契顧問,宣道會《宣訊月刊》顧問,《號角月報》、 《傳媒春秋》專欄作者。 書 名:《亞洲基督教史卷一》 作 者:莫菲特 譯 者:中國神學研究院、中國文化研究中心 出 版 社:基督教文藝 出版日期:2008年(第三版) 基督教發源於耶路撒冷,屬於亞洲宗教,但是許 多人至今仍將基督教誤解為西方的宗教。 早期基督教從耶路撒冷傳播到整個近東。公元 380年成為羅馬帝國國教。公元431年以弗所公會議 後,聶斯脫利派分離,形成東方亞述教會。之後在公 元451年迦克墩公會議,教會又分裂為東方正統教會 和迦克墩教會。公元 1054 年東西教會大分裂使得迦 克墩教會再分裂為羅馬天主教會和希臘東正教會。16 世紀的宗教改革運動,新教從天主教會分離出來。 在漫長的發展過程中,東方教會一直對亞洲具有 很大影響,包括敘利亞、波斯等地區。然而,長久而 來,我們對東方教會幾乎一無所知。最初將基督教帶 來中國的,是聶斯脫利派的景教傳教士,他們是敘利 亞的傳教士,在著名的《大秦景教流行中國碑》中, 保留許多傳教士的敘利亞名字。 根據普林斯頓神學院基督教教會史專家莫菲特在 《亞洲基督教史卷一》寫道:敘利亞版本的舊約和福 音書有別於西方教會的版本,他們的《舊約聖經》 並非採用七十士譯本,也不是希伯來文的原文聖經, 而是巴勒斯坦會堂的阿蘭文譯本。 在東方,公元410年的以撒會議,確立了西基 泰西封的主教作為全國教會的權力中心。今天,我 們對泰西封( Ctesiphon )一無所知,但是這座位 於伊拉克首都巴格達底格里斯河河畔的故城,一直 是Khvarvaran 省的首府。《舊約聖經》的《以斯拉 記》,提及泰西封(譯成「迦西斐雅」)。 聶斯脫利派的傳教士熱心向東方傳教,他們沿着 昔日的絲綢之路,在唐朝時來到中國,受到唐代皇帝 的歡迎。如果我們參考如石雲濤的《三至六世紀絲綢 之路的變遷》等書籍,或許會更能探索出從泰西封至 長安的路線。聶斯脫利派的傳教士翻譯了最初中文版 的《聖經》,卻帶有濃厚的佛教詞彙。 如果我們想更了解基督教的發展和《聖經》入 華的傳播,《亞洲基督教史卷一》是一本資料詳盡的 史書。 亞洲基督教史卷一












地址:旺角彌敦道720- 722號家樂樓10字樓1002 - 1003室 銅鑼灣羅素街8號英皇珠寶鐘錶珠寶中心8樓8B室 查詢:電話3110 8338 (旺角店) / 3110 8339 (銅鑼灣店) 電郵:greenpastures.hk@gmail.com 網址:www.greenpastures.hk 5111 9302 青草地皮膚專業護理中心 Green Pastures Pro Care Centre VIVACE 第二代白金膠原修復槍 意大利 Biotec Inlight 全球最頂尖修復技術 射頻驅動的膠原導管,可用於大部分皮膚 類型和膚色,甚至眼周的敏感位置,射頻 有效使皮膚細胞結構重組,促進膠原增生, 並有效改善並有效改善暗瘡、凹凸洞、毛 孔粗大、黑眼圈、收細眼袋、皺紋及抗衰 老等皮膚問題。 採用平面脈衝光技術(CPL)和真空光技術(VAL) 提升脈衝光的準繩度,令能量更有效地被皮膚吸收 原理:膠原導管進入表皮開啟微細管道, 激活皮膚細胞癒合及更生。當膠原導管 進入真皮層後發放射頻熱能,有效進行 膠原修復,透過刺激生長因子,形成天 然膠原蛋白和彈性蛋白,是最精準的射 頻治療方式。 分段式微輸送射頻技術 5 大顯示功效 達致 合真空光技術及平面脈衝光技術, 撫平凹凸洞 幼紋減淡 收細毛孔 緊緻白滑 打造 減淡賀爾蒙斑、老人斑、雀斑、淡化色素問題,達至淨白肌膚 減少痤瘡形成及平衡肌膚油脂分佈 有效改善毛孔粗大問題 改善毛髮倒生。毛囊炎、以及所引致膚色暗沉和暗沉 適合不同膚色和毛髮顏色(白色的毛髮除外) 脫毛 淡化色素 收細毛孔 改善痤瘡 改善膚質 V面提升 減淡頸紋 激活膠原增生 逆齡美肌 減淡動態紋/靜態紋 激退暗瘡印 皮膚重塑 專業之選 嫩膚更生









































生活文化 ‧愛.閱讀| ART / JL 生 作 者:麥張偉芬 定 價:港幣78元 出 版 社:更新資源 銷售地點:基督教書室 作 者:約翰‧麥卡瑟 譯 者:楊海利 定 價:港幣130元 出 版 社:麥種傳道會 銷售地點:基督教書室 父母及兒女的屬靈生 命是必需用上帝的話語去打 磨,更要磨出刃來,好好地領 受生活的智慧和力量。本書有 26篇實踐信息,若每 周舉行一次「家庭祭壇」,這是半年的材料。適合中 學生及以上年紀,並團契及小組舉行查經之用,值得 大家討論及應用心得。 本書查考使徒們在主權 爭議問題上教導的主要教義: 信心、恩典、悔改、稱義、 成聖、罪、行為、確據、恆 忍,以及福音信息。結果,一個清晰的事實呈現出 來:耶穌所傳的福音和使徒們所傳的福音是一樣的。 它要求的信心不是死的,而是活的;它是有悔改、降 服、信靠,以及產生好行為的持續信心。 《家庭祭壇》 《使徒們所傳的福音》 作 者:阿爾文.奧斯汀 譯 者:李楠 定 價:港幣219元 出 版 社:中原大學基督教與華人文化社會 研究中心、台灣基督教文藝 銷售地點:基督教書室 本書一方面在宏觀上展示以中國內地會為代表的 基要主義團體在 19世紀到20世紀的發展歷程,在微 觀上聚焦戴德生的傳教助手 群體,展示他們身上鮮明的 個性和時代特性;另一方面 聚焦於該時期基要派基督教 在中國本土化乃至變成中國 人的基督教的歷程,展示了 該過程中,中國內地會鮮為 人知的一面。 《中國億兆》 作 者:楊柏滿 定 價:港幣78元 出 版 社:楊柏滿 銷售地點:基督教書室 本書共有30章,分為 兩部分:一 )寶訓恩言, 取材自《馬太福音》5-7 章,是門徒品格的標準,包 括誠信、饒恕、憂慮、愛仇 敵等題目。二)福音大愛,取材自福音書及其他新約 經卷,包括福音真義、得救確據、愛的真諦,和天國 奥秘等題目。 《輕嚐淺酌主恩言》 26篇實踐信息若 每 96






















創世電視節目表 或瀏覽www.creation-tv.com/ctv_hk/index.php/timetable JANUARY 1月 節目 精選 何偉強牧師——羅馬書看信仰生活化的挑戰 何偉強牧師從《羅馬書》 看基督徒的個人信仰,如 何做到「入世而出世」; 肢體間如果做到恩賜配 搭、彼此相愛,並探討基 督徒在社會的參與、生活 倫理、奉獻及差傳等。 1月10日(星期二) 上午9時 金色的約定 節目由演出電影《下一 站‧再愛你》的中國內 地演藝人劉鑫主持,邀請 台灣金鐘獎電視電影男主 角得主李天柱、包攬六個 項目獎項的劇集《一把 青》導演曹瑞原、曾是台灣當紅童星的紀寶如、資深演 藝人喬宏太太小金子等,分享與上帝同行精彩的生命。 1月24日(星期二)晚上10時30分 金三角孫一刀傳奇 緬甸金三角毒梟橫行、軍 閥混戰、瘟疫流行,每天 都有大量人死亡。外號 「孫一刀」的孫中平醫生, 在雲南深山與金三角義診 數十年,曾被美國總統邀 請到白宮參加總統早餐會,卻連一套整齊的西裝也沒 有。對人無私的大愛,令他散發出無可比擬的亮光。 1月20日(星期五) 上午11時30分 《生命傳愛的故事》由不 同背景、不同行業的人物 代表作分享,包括醫「心」 醫生、帶病行醫的醫生資 深教育工作者、遺體防腐 師、支援及送別病人的醫 院牧者、以使命以愛心建立孩子未來的保險顧問,透過 他們活出火炬般生命的故事,傳遞愛的亮光。 生命傳愛的故事 1月17日(星期二)下午4時30分 聖地流動教室——以色列破謎之旅 梁燕城博士以他獨特的說 故事方式,與你窺探聖地 以色列,尋找耶穌基督隱 世遺跡。無數的以色列考 古發現,真實地證明了耶 穌並不是一個虛構人物, 祂曾經親自來到人間,透過十字架,將罪和痛苦化為愛 的能力! 1月2日(星期一) 上午11時 香港聖樂團——謝恩讚美頌 為慶祝香港特區成立25 周年,香港聖樂團深感榮 幸獻上音樂會《謝恩讚美 頌》。節目首先有孟德爾 遜的《以利亞》神曲 (選 段) 。接着曲目是音樂總 監陳永華教授的《第四交響曲-謝恩讚美頌》。 1月1日(星期日) 晚上8時
0:30 聖經實戰攻略:黃育才牧師-信仰
1:00 香港聖樂團-謝恩讚美頌 (2022)
1:30 生命傳愛的故事
2:00 屬靈教室:何偉強牧師-羅馬
書看信仰生活化的挑戰
2:30 聖地流動教室-以色列破謎之旅
3:00 聖誕屬靈教室:聖誕節的真 義-活在上帝救恩中
3:30 主日講壇 2021
4:00 屬靈教室:蔡錦圖博士-保羅腳蹤
4:30 敬拜唱不停
5:00 主日講壇 2021
5:30 揭開死海古卷之謎
6:00 靈修早晨
8:00 世界生命之道:鄺保亮牧師
8:30 創世主日學堂:葉劍華牧師-研經有招式
9:00 屬靈教室:李盛林院長-忍耐 的愛與難捨的愛
9:30 劉彤牧師-跨越的人生空中講台(2019)
10:00 生命真道-喬依絲邁爾牧師
10:30 寇紹涵牧師-哥林多前書
11:30 揭開死海古卷之謎
12:00 英文拼音王
12:30 Music Eternity
12:45 麥希真牧師 末了的話 豐盛的生命
13:00 聖誕屬靈教室:聖誕節的真 義-活在上帝救恩中
13:30 創世主日學堂:葉劍華牧師研經有招式
14:00 讚美之泉(2023)
14 : 30 香港聖樂團-謝恩讚美頌 (2022)

15:00 聖經實戰攻略:黃育才牧師-信仰
15:30 屬靈教室:何偉強牧師-羅馬 書看信仰生活化的挑戰
16:00 聖地流動教室-以色列破謎之旅
16:30 屬靈教室:李盛林院長-忍耐 的愛與難捨的愛
17:00 英文拼音王
17:30 世界生命之道:鄺保亮牧師
18:00 敬拜唱不停
18:30 麥希真牧師 末了的話 豐盛的生命
19:30 來!為這城禱告
20:00 創世主日學堂:葉劍華牧師研經有招式
20:30 屬靈教室:蔡錦圖博士-保羅腳蹤
21:00 屬靈教室:蘇穎睿牧師-信心之旅
21:30 屬靈教室:何偉強牧師-羅馬 書看信仰生活化的挑戰
22:00 聖地流動教室-以色列破謎之旅
22:30 喜樂家庭2-父母篇 (梁藝齡)
23:00 聖誕屬靈教室:聖誕節的真
義-活在上帝救恩中
23:30 聖經實戰攻略:黃育才牧師-信仰
敬拜唱不停
1月9日(一)
0:00 讚美之泉(2022)
0:30 生命傳愛的故事
1:00 聖誕屬靈教室:聖誕節的真 義-活在上帝救恩中
1:30 生命真道-喬依絲邁爾牧師
2:00 世界生命之道:鄺保亮牧師
2:30 劉彤牧師-跨越的人生空中講台(2019)
3:00 創世主日學堂:葉劍華牧師-研經有招式
3:30 福氣教會講道系列
4:00 揭開死海古卷之謎
4:30 寇紹涵牧師-哥林多前書
5:30 敬拜唱不停
6:00 靈修早晨
8:00 溫偉耀博士普通話講道精選

8:30 屬靈教室:蘇穎睿牧師-信心之旅
9:00 生命的觸動(Charles Stanley) 2022


9:30 屬靈教室:李盛林院長-忍耐 的愛與難捨的愛
10:00 劉彤牧師-跨越的人生空中講台(2019)
10:30 福氣教會講道系列
11:00 聖地流動教室-以色列破謎之旅
11:30 創世主日學堂:葉劍華牧師研經有招式
0:00 讚美之泉(2023)
0:30 屬靈教室:蘇穎睿牧師-信心之旅
1:00 世界生命之道:鄺保亮牧師
1:30 聖地流動教室-以色列破謎之旅
2:00 敬拜唱不停
2:30 溫偉耀博士普通話講道精選
3:00 聖經實戰攻略:黃育才牧師-信仰
3:30 主日講壇 2023
4:00 生命真道-喬依絲邁爾牧師
4:30 屬靈教室:李盛林院長-忍耐 的愛與難捨的愛
5:00 主日講壇 2023
5:30 劉彤牧師-跨越的人生空中講台(2019)
6:00 靈修早晨
12:00 英文拼音王
12:30 Music Eternity
12:45 麥希真牧師 末了的話 豐盛的生命
13:00 喜樂家庭2-父母篇 (梁藝齡)
13:30 生命傳愛的故事
14:00 讚美之泉(2023)
14:30 世界生命之道:鄺保亮牧師
15:00 聖誕屬靈教室:聖誕節的真 義-活在上帝救恩中
15:30 聖經實戰攻略:黃育才牧師信仰
16:00 屬靈教室:蘇穎睿牧師-信心 之旅
16:30 屬靈教室:何偉強牧師-羅馬 書看信仰生活化的挑戰
17:00 英文拼音王
17:30 屬靈教室:李盛林院長-忍耐 的愛與難捨的愛
18:00 敬拜唱不停
18:30 麥希真牧師 末了的話 豐盛的生命
19:30 來!為這城禱告
20:00 揭開死海古卷之謎
20:30 屬靈教室:蔡錦圖博士-保羅腳蹤
21:00 福氣教會講道系列
21:30 劉彤牧師-跨越的人生空中 講台(2019)
22:00 生命真道-喬依絲邁爾牧師
22:30 聖地流動教室-以色列破謎之旅
23:00 生命傳愛的故事
23:30 創世主日學堂:葉劍華牧師研經有招式
13:30 聖地流動教室-以色列破謎之旅 14:00 讚美之泉(2023) 14:30 福氣教會講道系列 15:00 屬靈教室:蘇穎睿牧師-信心之旅 15:30 劉彤牧師-跨越的人生空中 講台(2019)
16:00 世界生命之道:鄺保亮牧師
16:30 生命傳愛的故事
17:00 英文拼音王
17 : 30 寇紹涵牧師-哥林多前書
18:30
末了的話
溫偉耀博士普通話講道精選 1月6日(五)13:30 權能時間2023 1月8日(日)9:00 1月 7日(六)8:00 1月10日(二)16:30
0:00 讚美之泉(2023)
1月6日(五)
0:00 讚美之泉(2023) 0:30 生命傳愛的故事 1:00
義-活在上帝救恩中
生命真道-喬依絲邁爾牧師 2:00 世界生命之道:鄺保亮牧師 2:30 劉彤牧師-跨越的人生空中講台(2019) 3:00 創世主日學堂:葉劍華牧師-研經有招式 3:30 福氣教會講道系列 4:00 揭開死海古卷之謎 4:30 寇紹涵牧師-哥林多前書 5:30 敬拜唱不停 6:00 靈修早晨 8:00 溫偉耀博士普通話講道精選 8:30 屬靈教室:蘇穎睿牧師-信心之旅 9:00 生命的觸動(Charles Stanley) 2022 9:30 屬靈教室:李盛林院長-忍耐 的愛與難捨的愛 10:00 劉彤牧師-跨越的人生空中講台(2019) 10:30 福氣教會講道系列 11:00 聖地流動教室-以色列破謎之旅 11:30 創世主日學堂:葉劍華牧師研經有招式 1月7日(六) 12:00 英文拼音王 12:30 Music Eternity 12:45 麥希真牧師 末了的話 豐盛的生命 13:00 喜樂家庭2-父母篇 (梁藝齡) 13:30 生命傳愛的故事 14:00 讚美之泉(2023) 14:30 世界生命之道:鄺保亮牧師 15:00 聖誕屬靈教室:聖誕節的真 義-活在上帝救恩中 15:30 聖經實戰攻略:黃育才牧師-信仰 16:00 屬靈教室:蘇穎睿牧師-信心 之旅 16:30 屬靈教室:何偉強牧師-羅馬 書看信仰生活化的挑戰 17:00 英文拼音王 17:30 屬靈教室:李盛林院長-忍耐 的愛與難捨的愛 18:00 敬拜唱不停 18:30 麥希真牧師 末了的話 豐盛的生命 19:30 來!為這城禱告 20:00 揭開死海古卷之謎 20:30 屬靈教室:蔡錦圖博士-保羅 腳蹤 21:00 福氣教會講道系列 21:30 劉彤牧師-跨越的人生空中 講台(2019) 22:00 生命真道-喬依絲邁爾牧師 22:30 聖地流動教室-以色列破謎之旅 23:00 生命傳愛的故事 23:30 創世主日學堂:葉劍華牧師研經有招式 0:00 讚美之泉(2023) 0:30 喜樂家庭2-父母篇
1:00 生命傳愛的故事 1:30 劉彤牧師-跨越的人生空中講台(2019)
生命真道-喬依絲邁爾牧師 4:30 敬拜唱不停 5:00 揭開死海古卷之 5:30 屬靈教室:李盛林院長-忍耐 的愛與難捨的愛 6:00 靈修早晨 8:00 福氣教會講道系列 8:30 劉彤牧師-跨越的人生空中講台(2019) 9:00 權能時間 2023 9:30 聖誕屬靈教室:聖誕節的真 義 - 活在上帝救恩中 10:00 主日講壇 2023 10:30 屬靈教室:蘇穎睿牧師-信心之旅 11:00 主日講壇 2023 11:30 屬靈教室:蔡錦圖博士-保羅腳蹤 1月8日(日) 12:00 英文拼音王 12:30 生命的觸動(Charles Stanley) 2022 13:00 聖地流動教室-以色列破謎之旅 13:30 屬靈聖誕教室:聖誕節的真 義-活在上帝救恩中 14:00 讚美之泉(2023) 14:30 創世主日學堂:葉劍華牧師研經有招式 15:00 敬拜唱不停 15:30 生命真道-喬依絲邁爾牧師 16:00 聖經實戰攻略:黃育才牧師-信仰 16:30 揭開死海古卷之謎 17:00 英文拼音王 17:30 溫偉耀博士普通話講道精選 18:00 屬靈教室:蘇穎睿牧師-信心 之旅 18:30 麥希真牧師 末了的話 堅穩的 根基 18:45 Music Eternity 19:00 權能時間 2023 20:00 屬靈聖誕教室:聖誕節的真 義-活在上帝救恩中 20:30 喜樂家庭2-父母篇 (梁藝齡) 21:00 屬靈教室:李盛林院長-忍耐 的愛與難捨的愛 21:30 聖經實戰攻略:黃育才牧師-信仰 22:00 生命傳愛的故事 22:30 屬靈教室:蔡錦圖博士-保羅腳蹤 23:00 聖地流動教室-以色列破謎之旅 23:30
聖誕屬靈教室:聖誕節的真
1:30
(梁藝齡)
2:00 溫偉耀博士普通話講道精選 2:30 聖誕屬靈教室:聖誕節的真 義-活在上帝救恩中 3:00 寇紹涵牧師-哥林多前書 4:00
10:00 創世主日學堂:葉劍華牧師-研經有招式 10:30 世界生命之道:鄺保亮牧師 11:00 屬靈教室:蘇穎睿牧師-信心之旅 11:30 喜樂家庭2-父母篇
1月10日(二) 12:00 英文拼音王
Music Eternity
麥希真牧師 末了的話 豐盛的生命
屬靈教室:李盛林院長-忍耐
8:00 聖經實戰攻略:黃育才牧師-信仰 8:30 揭開死海古卷之謎 9:00 溫偉耀博士普通話講道精選 9:30 屬靈教室:何偉強牧師-羅馬 書看信仰生活化的挑戰
(梁藝齡)
12:30
12:45
13:00
的愛與難捨的愛
麥希真牧師
豐盛的生命 18:45 Music Eternity 19:00 2023靈情詩歌 19:30 揭開死海古卷之謎 20:00 生命傳愛的故事 20:30 屬靈教室:何偉強牧師-羅馬 書看信仰生活化的挑戰
創世主日學堂: 葉劍華牧師-研經有招式 生命傳愛的故事
21:00 聖誕屬靈教室:聖誕節的真 義-活在上帝救恩中 21:30 屬靈教室:蔡錦圖博士-保羅腳蹤 22:00 創世主日學堂:葉劍華牧師研經有招式 22:30 金色的約定 23:00 屬靈教室:李盛林院長-忍耐 的愛與難捨的愛 23:30 聖地流動教室-以色列破謎之旅

使命人生 黑皮古玉 訴說洪水滅世前的人類歷史 萬人見證 陶造生命之聖詩 譚靜芝博士 200 JAN 2023 J 吳宗文牧師 封面故事 由苦瓜乾到喜樂婆婆 小金子九十載屬天路 絲路福音 百年光影,從《倫敦蒙難記》 到《生命因祢傳奇》 「兔」氣揚眉 吳宗文牧師















































































































































































































































































































































































































































































































































































































































































































































































































































































































































